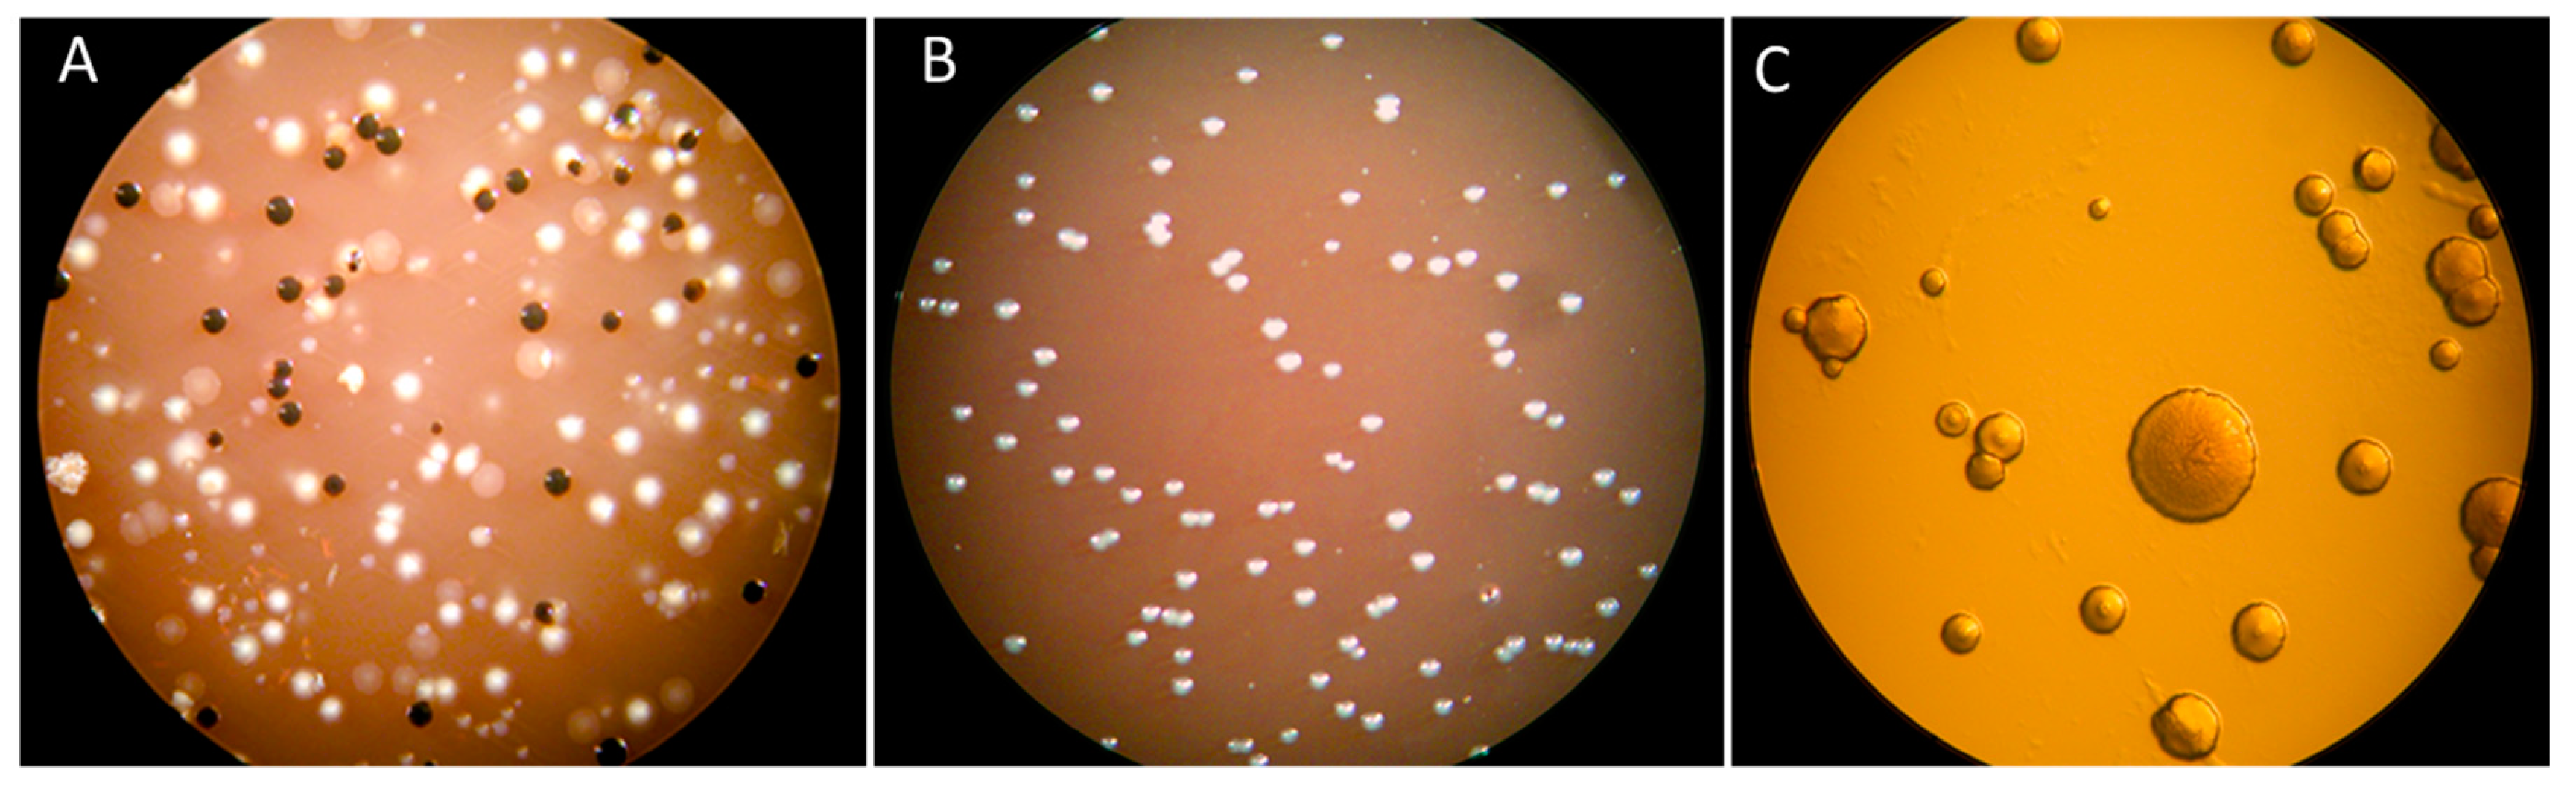
Pathogens 08 00222 g001 Pathogens 08 00222 g001

Abstract
Aggregatibacter actinomycetemcomitans is a periodontal pathogen colonizing the oral cavity of a large proportion of the human population. It is equipped with several potent virulence factors that can cause cell death and induce or evade inflammation. Because of the large genetic diversity within the species, both harmless and highly virulent genotypes of the bacterium have emerged. The oral condition and age, as well as the geographic origin of the individual, influence the risk to be colonized by a virulent genotype of the bacterium. In the present review, the virulence and pathogenicity properties of A. actinomycetemcomitans will be addressed.
1. Introduction
Aggregatibacter actinomycetemcomitans is a facultative anaerobic Gram-negative bacterium that expresses several virulence factors, which activates a host response that could be associated to the pathogenesis of periodontitis [1]. This review will elaborate in more detail the virulence properties of A. actinomycetemcomitans that contribute to the increased pathogenicity of this species, particularly with regard to early and rapidly progressive forms of periodontal disease [2,3], such as localized aggressive periodontitis, where it is frequently a predominant find (Figure 1). The “crown jewel” of the virulence factors of A. actinomycetemcomitans has long been its leukotoxin [4,5]. However, a cytolethal distending toxin (CDT) has also been identified, making this species the only member of the oral microbiome to produce these two, or any of the two, protein exotoxins [6]. Its lipopolysaccharide is quite special in that the immunological responses elicited by the host can be used in classifying (serotyping) the virulence identity of each one of its strains [7]. More recently identified cytokine-binding molecules add to its potential virulence factors, suggesting additional pathogenicity mechanisms by which it can manipulate the host [8]. A. actinomycetemcomitans is also equipped with a wealth of outer membrane vesicles, like all Gram-negative species, which might confer special virulence properties to this species [9]. There is a great genetic diversity within this species, with base composition biases in the genomic islands suggesting their acquisitions via horizontal gene transfer [10]. Recent advances in biofilm modeling and proteomic technologies have helped define the localization of A. actinomycetemcomitans within biofilms, characterize the full range of its protein components, and define how these are regulated by other species, and vice versa, when growing within complex polymicrobial communities [11]. Increased knowledge about bacterial virulence markers in periodontal disease may be important tools in future strategies for personalized dentistry [12].
Figure 1.
Subgingival biofilm samples from pathological periodontal pockets cultivated on blood agar plates for 48 h at 37 °C in an anaerobic atmosphere. (A) Sample obtained from a periodontal pocket of a middle-aged patient diagnosed with generalized chronic periodontitis. The macroscopical observation of the plated sample showed occurrence of a variety of colonies corresponding to different bacterial species. (B) Sample obtained from a periodontal pocket of a 25-year-old patient diagnosed with localized aggressive periodontitis. The macroscopical observation of the plated sample showed predominantly the occurrence a single colony type. (C) Microscopical (50× magnification) examination indicated that all colonies belonged to the A. actinomycetemcomitans species, which was confirmed in assays based on genetic characterization.
2. Leukotoxin (LtxA)
The leukotoxin (LtxA) of A. actinomycetemcomitans affects the different leukocyte populations with various death mechanisms [4]. It activates neutrophil degranulation causing a massive release of lysosomal enzymes, net-like structures, and matrix metallo proteinases (MMPs) and induces apoptosis in lymphocytes [13,14,15]. Interestingly, net-like structures can also be released from the LtxA-exposed neutrophils under anaerobic conditions and contain citrullinated proteins with sequence homology to proteins found in inflamed joints [16,17]. In the monocytes/macrophages, the toxin activates the inflammasome complex including the cysteine proteinase caspase-1, which induces an activation and secretion of the pro-inflammatory cytokines IL-1β and IL-18 [2,18,19]. These cellular and molecular mechanisms have been previously described in detail [20] (Figure 2). Taken together, several of the mechanisms by which LtxA affects leukocytes are also involved in the pathogenic mechanisms of many inflammatory disorders, such as periodontitis [21]. LtxA show a high target cell specificity expressed and affect only cells of hematopoetic origin from humans and some other primates [5]. This species-specificity of LtxA is reported to act through a unique target cell receptor and a specific region in the toxin that recognizes and interacts with this receptor [22,23]. A region of LtxA contains a series of 14 tandemly repeated amino acid sequences in the repeat region of the toxin and are shown to be responsible for the receptor binding to Lymphocyte function–associated antigen 1 (LFA-1) [4,23]. The LFA-1 molecule is a heterodimer consisting of the αL (CD11a) and β2 (CD18) subunits and is suggested to help the toxin to have a correct orientation on the target cell membrane [24,25,26,27].
Figure 2.
Leukotoxin (LtxA) induces a rapid inflammatory cell death in human macrophages. Briefly, LtxA binds to the LFA-1 receptor (1) and induces an extracellular release of ATP (2), which act as a ligand for the P2X7-receptor and result in an efflux of potassium (3). These processes promote the formation of an inflammasome multimer (4) that activates the cysteine proteinase caspase-1, resulting in a rapid activation (5) and secretion of IL-1β (6). Courtesy of Haubek and Johansson [20].
2.1. LtxA Production
The LtxA operon belongs to the core genome of A. actinomycetemcomitans and is so far present in all examined strains [28]. The operon consists of four coding genes named ltxC, ltxA, ltxB, and ltxD and an upstream promoter region [29]. The gene ltxA encodes the LtxA protein, ltxC a protein required for the posttranslational acylation of LtxA, and ltxB and ltxD proteins needed for the transport of the LtxA to the bacterial outer membrane. For regulation of the LtxA expression, there is a promoter region located upstream of the ltxC gene, and genetic differences within this region result in different genotypes with various LtxA expression [10].
Zambon [30] reported that leukotoxicity of A. actinomycetemcomitans isolated from individuals with periodontitis was enhanced compared with isolates from individuals without periodontitis. Later, it was discovered that many of the isolates with enhanced leukotoxicity have been shown to have a different type of promoter in the leukotoxin operon [29]. A specific genotype (JP2) of A. actinomycetemcomitans with enhanced leukotoxicity has been shown to significantly correlate to disease onset in infected individuals [31,32]. The JP2 genotype was first identified by Brogan and co-workers [33] and was a serotype b isolate with a 530 base pair (bp) deletion in the ltxCABD promoter. Based on this finding, isolates with such a deletion in the promoter are named JP2 genotype, and those lacking this deletion are non-JP2 genotype [20,34]. The discovery of the JP2 genotype introduced a new terminology of high and low leukotoxic A. actinomycetemcomitans based only on the ltx promoter type [33,35]. The presence of the JP2 genotype is highly associated to adolescents of North and West African origin [31,36]. However, the JP2 genotype has recently been shown to also colonize individuals of other geographic origin, as confirmed by genotyping [37,38]. Alterations in the ltx promoter region are the most studied genotypes associated with enhanced LtxA expression. In addition to the JP2 genotype, an insertion of 886 bp, as well as a 640 bp deletion in the ltx promoter, has been discovered in A. actinomycetemcomitans isolates [39,40]. These three different genotypes are all associated with high virulence due to enhanced production of LtxA. Whether the deletions or insertions per se are causing the increased leukotoxin production is not entirely clear.
Enhanced leukotoxicity has been reported from serotype b isolates with an intact ltx promoter region, indicating a high production of the toxin [41]. These isolates represent a subgroup of serotype b with a high association with disease progression in the infected individual. Genetic characterization of this subgroup showed a genetic pattern with similarities to that of the JP2 genotype, and such strains are frequently carried by young individuals with periodontitis [2,38,42]. A specific genetic marker (cagE) correlates to A. actinomycetemcomitans with enhanced leukotoxicity, including the JP2 genotype and other virulent serotype b isolates [42,43]. Interestingly, the activity of LtxA has been reported to be involved in induction of systemic autoantibodies to citrulline, which are risk markers for rheumatoid arthritis [17,44]. In addition, LtxA has a crucial role in sepsis induced by bacteremia in an animal model [45].
2.2. Leukotoxin Secretion
The secretion of LtxA is mediated by a Type I secretion system in line with other proteins of the repeat in toxin (RTX family) expressed by several Gram-negative pathogens [46,47,48]. A unique property for LtxA among the RTX proteins is that the secreted toxin is reported to be associated to the bacterial outer membrane [47]. The export of the toxin to the bacterial outer membrane has been shown to require expression of three proteins—LtxB, LtxD, and TdeA—for export of the toxin to the bacterial outer membrane, and a fourth—LtxC—for the acylation [49]. In addition, the inner membrane protein MorC, which affects the outer membrane structure, has been reported to be necessary for efficient export of the toxin [50]. The localization of LtxA was found to be on the outside of the bacterial membrane and on vesicles associated to the outer membrane [51,52]. The responsible mechanisms for the association of LtxA to the membrane are still not fully clarified, and whether the secreted LtxA remains associated to the bacterial outer membrane or is released to the environment is a topic of controversy. A suggestion is that the hydrophobic domain of LtxA mediates the association to the bacterial membrane [27]. Ohta and co-workers [53,54] reported that LtxA could be released from the bacterial membrane by DNase or RNase treatment, which indicates involvement of electrostatic forces between the negatively charged nucleic acid and the positively charged LtxA. This phenomenon was later supported by the observation that LtxA on the bacterial membrane and on vesicles was released in hypertonic NaCl solutions [55]. LtxA was also released from the bacterial membrane in presence of serum proteins, which indicates involvement of competitive mechanisms [56]. Differences in the culture media have been shown to determine the distribution of the produced LtxA between the bacterial outer membrane and the culture supernatant [56,57,58]. Whether LtxA is associated with the bacterial membrane or released to the environment at the infected site in vivo is still not known. However, the serum mediated release of the LtxA [56], as well as the activation of a systemic immunogenic response [59,60], indicates a release of LtxA from bacteria growing in an in vivo oral biofilm.
The secreted LtxA has been shown to be efficiently inactivated by proteases and superoxide radicals [55,61,62]. In 1981, McArthur and co-workers reported that the activity of LtxA in interaction with polymorphonuclear leukocytes (PMNs) was enhanced in the presence of human serum [63]. This phenomenon could later be explained by the protective effect of the serum protease inhibitors on the proteolytic enzymes released from LtxA challenged PMNs that degrades the toxin [56,64].
2.3. Quantification of LtxA Production
The great genetic diversity of A. actinomycetemcomitans has resulted in various genotypes with substantially different virulence properties, i.e., LtxA production [10,28]. The expression of LtxA is also influenced by environmental factors, such as growth conditions and substrates [46]. Notably, an anaerobic culture condition enhances substantially the production of LtxA, which mirrors the condition in the periodontal pocket [65].
Due to the complex regulation of ltxA expression, the balance between membrane-associated and secreted toxin, as well as its sensitivity to proteolytic degradation, a gold standard for quantification of LtxA production, is still not available. The first attempt to quantify LtxA activity was to add bacteria to isolated leukocytes and determine cell death by trypan blue exclusion [66]. In a study by Zambon and co-workers [67], the leukocyte lysis method was used to discriminate between leukotoxic and non-leukotoxic strains. This study showed that the prevalence of more leukotoxic variants of A. actinomycetemcomitans was higher in young individuals with periodontitis than in older individuals with the disease or in periodontally healthy individuals.
Except for examining the leukotoxicity of the isolates, methods targeting gene expression or immunodetection have been developed [58,68]. These methods have been employed on a limited number of A. actinomycetemcomitans isolates and support findings from previous leukotoxicity determinations, with enhanced expression in the JP2 genotype [69,70]. To obtain a gold standard for quantification of leukotoxicity of isolated A. actinomycetemcomitans is one of several challenges for future research.
3. Cytolethal Distending Toxin (CDT)
The CDT family comprises a number of bacterial protein exotoxins that is expressed by several Gram-negative species. Due to its deleterious effects on the host, as revealed in various experimental models, CDTs are likely to be involved in the etiopathogenesis of the associated human infections. They can be described as genotoxins, as their main action is to elicit DNA damage upon the intoxicated host cells [71]. The CDT holotoxin consists of subunits CdtA, CdtB, and CdtC. While CdtA and CdtC subunits mediate the internalization of the CdtB into the cell, the latter is translocated to the nucleus, causing its deleterious effects on the host cells. This subunit is functionally homologous to deoxyribonuclease I, hence it can cause DNA damage. It is postulated that CdtB internalization occurs via a mechanism involving the recognition of cell membrane cholesterol by both CdtC and CdtB [72,73].
A. actinomycetemcomitans expresses a CDT and is the only known oral species with this property. An estimated 66% to 86% of its strains express a CDT, and its presence has been associated with the occurrence of periodontal disease [74]. It is very plausible that its pathogenic effects are related to its capacity to cause DNA damage, cell cycle arrest, and eventually apoptosis to the intoxicated cells. This has been shown in structural cells like gingival fibroblasts and periodontal ligament cells [75,76], gingival epithelial cells [77,78,79,80], or gingival tissue explants [79], denoting that it can compromise the structural integrity and homeostatic capacity of the tissues. The capacity of CDT to affect the gingival epithelium has also been shown in human gingival explants [81], as well as in vivo upon inoculation of the toxin on rat gingival tissue [82]. Cells of the immune system are also highly susceptible to the cell cycle–arresting and apoptotic action of CDT, as has been demonstrated in human T cell [83], B-cells [84], and mononuclear cells [85]. CDT may also subvert the phagocytic capacity of macrophages and subvert their cytokine producing capacity [85]. The deleterious effects of CDT on cells of the immune system denote an impairment of the local immunity, which may compromise the capacity of the periodontium to recognize and eliminate the bacterial challenge, be it A. actinomycetemcomitans or other microbial constituents of the biofilm community.
Another potentially pathogenic mechanisms activated by CDT is the stimulation of pro-inflammatory and osteolytic cytokine production by the intoxicated host cells [86]. It has been shown that CDT can stimulate the production of pro-inflammatory cytokines by peripheral blood mononuclear cells, such as interferon (IFN)-γ, Interleukin (IL)-1β, IL-6, and IL-8, a virulence property potentially independent of the toxin’s deoxyribonuclease I activity [85]. However, A. actinomycetemcomitans can stimulate the production of several pro-inflammatory cytokines and regulate inflammasome expression irrespective of its CDT, as demonstrated by the use of the CDT-deletion strains [87,88]. An important virulence property of CDT is revealed by its capacity to induce the major osteolytic factor receptor activator of nuclear factor kappa-B ligand (RANKL). This is a crucial molecule that stimulates the differentiation of osteoclasts and, consequently, bone resorption in periodontitis [89]. It has been shown that CDT induces RANKL expression and production in periodontal connective tissue cells, such as gingival fibroblasts and periodontal ligament cells [90,91], as well as T-cells [92]. This implies that the CDT may increase the levels RANKL in the periodontal tissues and therefore potentiate bone destruction by this action. The induction of inflammatory and bone-destructive molecular cascades in the periodontium by CDT may well constitute an additional mechanism through which A. actinomycetemcomitans is involved in the etiopathogenesis of periodontitis. On the other side of the bone remodeling equilibrium, when CDT acts directly on pre-osteoclasts, it may also induce apoptosis and hinder their differentiation to osteoclastic cells, thereby contributing a dysbalanced bone remodeling equilibrium that leads to periodontal breakdown [93].
4. Lipopolysaccharide and Cytokine-Binding Factors
4.1. The Virulence Properties of A. actinomycetemcomitans Lipopolysaccharide
Like other Gram-negative species, A. actinomycetemcomitans surface is covered by lipopolysaccharide (LPS), a potent pro-inflammatory molecule. A. actinomycetemcomitans LPS comprises a group of structurally related molecules in which the O-specific polysaccharide chain (O-antigen), formed by oligosaccharide repeating units, is the most variable portion (Figure 3).
Figure 3.
Schematic representation of a putative structure of the lipid A and the core oligosaccharides of A. actinomycetemcomitans lipopolysaccharide (LPS). The lipid A (black) of A. actinomycetemcomitans LPS is formed by four primary fatty acyl chains (myristic or 3-hydroxymyristic acid) linked by ester and amide linkages to a disaccharide of glucosamine. Two of the primary fatty acyl chains are esterified by secondary fatty acids. The acylation pattern of lipid A is asymmetric with four fatty acyl chains on the non-reducing glucosamine and two on the reducing glucosamine. The inner core (purple) is linked to lipid A by a ketosidic bond and is formed by 3-deoxy-D-manno-oct-2-ulosonic acid (Kdo) together with heptose residues such as glycero-manno-heptose. The outer core (green) usually consists of hexoses such as glucose and galactose. Functional groups such as hydroxyl and phosphate groups are common substituents in the lipid A and the core oligosaccharides. The O-specific polysaccharide chain (O-antigen) is the most variable portion in the LPS. The O-antigen consists of a large variety of sugar residues in many combinations and glycosidic linkages. For simplicity, substituents such as hydroxyl and phosphate groups (other than those in lipid A), conformational details of the monosaccharide residues, and the stereochemistry of the glycosidic bonds are not presented.
The serotyping of A. actinomycetemcomitans to seven different serotypes from a to f, as well as to non-serotypeable, is based on the structural differences in the O-antigen part of LPS. Commonly found monosaccharide residues in the A. actinomycetemcomitans O-antigen include the hexoses glucose, galactose, mannose, and talose; the hexosamines glucosamine and galactosamine; and the deoxyhexoses rhamnose and fucose. However, between different A. actinomycetemcomitans strains, there appears to be significant variation in the final architecture of the oligosaccharide repeating units, which may be either di-, tri-, or tetrasaccharide moieties [94,95,96,97]. Thus, variation in the gene clusters involved in the synthesis of the highly variable polysaccharide moieties serves as the basis for PCR serotyping of A. actinomycetemcomitans strains [94,98].
The structures of the core oligosaccharide and the lipid A in A. actinomycetemcomitans LPS have a lower degree of structural freedom than the O-antigenic polysaccharides. The core oligosaccharide consists of 3-deoxy-D-manno-oct-2-ulosonic acid (Kdo), glycero-manno-heptose, glucose, and galactose, and appears conserved among different serotypes [96,97]. The lipid A consists of two phosphorylated glucosamine residues [96,97] and primarily myristic and 3-hydroxymyristic acid as the fatty acyl chains [97,99,100,101,102]. Amino compounds such as ethanolamine and glycine are found associated with A. actinomycetemcomitans lipid A and core oligosaccharides but in fewer numbers than the commonly found hydroxyl and phosphate group substituents [97]. A. actinomycetemcomitans growth is favoured in slightly alkaline environments [103,104] in which the phosphate groups and the Kdo occur in deprotonated form. The phosphate groups and the Kdo interact with positively charged ions and participate in hydrogen bonding, and thus contribute to the stabilization of the bacterial outer membrane.
The fatty acyl composition of lipid A generally varies between different Gram-negative species. For example, in lipid A of Escherichia coli and Salmonella typhimurium LPS the relative amount of myristic acid is lower than in A. actinomycetemcomitans LPS, while lauric acid and palmitic acid are more frequently found [100]. The lipid A composition of closely related species may not always be specific enough to allow taxonomic differentiation, as demonstrated by the similar composition of A. actinomycetemcomitans and Aggregatibacter aphrophilus lipid A [100]. Closely related species may, however, be differentiated by the composition of their (core) oligosaccharides. A distinct feature of the oligosaccharides of A. actinomycetemcomitans is the presence of both D- and L-glycero-D-manno-heptose, whereas A. aphrophilus LPS only contains the L-enantiomer of this aldoheptose [105,106]. By contrast, galactose appeared twice as abundant in LPS from A. aphrophilus as in LPS from A. actinomycetemcomitans [99,105,106].
Although there are several studies that indicate a distinct effect of A. actinomycetemcomitans LPS on rodent cells [107,108,109,110,111], we will focus here on describing how A. actinomycetemcomitans LPS stimulates human cells. This outlining is done due to the known differences between the murine/rat and human immune systems [112]. The various virulence-related effects of A. actinomycetemcomitans LPS are summarized in Table 1. The first cells encountered by detached A. actinomycetemcomitans LPS in junctional epithelium (JE) of a tooth are the epithelial cells. These human epithelial cells have been shown to respond to A. actinomycetemcomitans LPS by expressing IL-15 which results in enhanced IFN-γ production and proliferation of human T cells [113]. Moreover, A. actinomycetemcomitans LPS causes widening of the intercellular spaces in primary tissue cultures mimicking the JE, a phenomenon not observed with Porphyromonas gingivalis LPS [113]. Various direct effects of A. actinomycetemcomitans LPS on the other main human gingival cell type, fibroblasts, have also been reported. Collagen is ingested and digested by gingival fibroblasts in balanced conditions of healthy gingiva. A. actinomycetemcomitans LPS is able to enhance the phagocytosis of collagen by fibroblasts which may result in imbalance in regeneration of the gingival tissue [114]. In addition to changes in cellular functions, A. actinomycetemcomitans LPS stimulate the production of IL-6 and IL-8 [114], tissue plasminogen activator (t-PA), and plasminogen activator inhibitor 2 (PAI-2) by human gingival fibroblasts [115]. The plasminogen/plasmin system is involved in the complex process of extracellular matrix degradation and renewal in the gingival tissue, a step that most likely precedes the collagen phagocytosis by the gingival fibroblasts.
Table 1.
Virulence-related properties of A. actinomycetemcomitans LPS.
Gingival tissue contains various resident immune cells, of which macrophages play a central role in periodontitis. A. actinomycetemcomitans LPS has shown to stimulate the expression of microRNA miR-146a [116], which downregulates the expression of TNF receptor–associated factor 6 and IL-1 receptor–associated kinase 1, which serves as a negative feedback loop in cytokine signaling [117]. On the contrary, high doses of A. actinomycetemcomitans LPS downregulated the expression of miR-32 and miR-29b, which target the pro-apoptotic factor Bim of acute myeloid leukemia cells [118] and IL-6 receptor α [117], respectively. Another human cell type that originates from mesenchymal stem cells is osteoblast which plays a significant role in bone formation. A. actinomycetemcomitans LPS has capacity to increase the inducible nitric oxide synthase (iNOS) activity and induce the nitric oxide (NO) production by human osteoblast-like cell line [119]. If osteoblasts produce NO rapidly, when responding to bacterial infection, it may lead to bone resorption [120].
Another type of resident immune cells in periodontium is dendritic cells (DCs), which are involved in antigen presenting to T cells. Conventional DCs originate from monocytes, like macrophages, and are called mDCs. Monocytes originating from localized aggressive periodontitis (LagP) patients, recently renamed molar-incisor pattern periodontitis with rapid progression [131], spontaneously give rise to mDCs [132]. A. actinomycetemcomitans LPS enhances the IL-12 production by mDCs leading to stimulation of IFN-γ expression of natural killer cells and undetectable levels of IL-4, which together may cause the polarization of naïve T cells toward the Th1 type response [123]. There are differences of DCs stimulation potential of A. actinomycetemcomitans LPS originating from different serotypes, serotype b LPS inducing the strongest production of IL-12, IFN-γ, TNF-α, IL-1β, IL-6, and IL-23 [124]. The differences in the response of DCs to serotype b A. actinomycetemcomitans LPS compared to the response to other serotype LPS most likely causes Th1/Th17 type of T cell response in serotype b related infection [133].
PMNs are innate immune cells which may play both defensive and destructive role in periodontitis [134]. Neutrophils produce reactive oxygen species (ROS) when responding to whole bacteria or their components. A. actinomycetemcomitans LPS has been shown to be more potent inducer of neutrophil ROS production than, for example, P. gingivalis or Prevotella intermedia LPS [125]. Moreover, A. actinomycetemcomitans LPS stimulate the production of inflammatory cytokines IL-1β and TNF-α by PMN more efficiently than P. gingivalis LPS [126], and in human whole blood, A. actinomycetemcomitans LPS causes higher production of the above mentioned cytokines as well as IL-6 than E. coli LPS [127]. A. actinomycetemcomitans LPS can shift the movement of monocytes and granulocytes from rolling to the passaging through the vascular wall by downregulating the surface expression of L-selectin and increasing the expression of β2 integrins, respectively [128].
Despite the vast literature concerning the inflammatory related functions of A. actinomycetemcomitans LPS, this outer membrane linked polysaccharide has also functions related to bacterial physiology. The serotype specific O-antigen part of A. actinomycetemcomitans LPS takes part in the secretion of leukotoxin, since a serotype b mutant with inactive rmlC and altered O-antigen sugar composition, contained more cytoplasmic and membrane-bound leukotoxin, and secreted less leukotoxin than the wild-type serotype b strain [135]. Moreover, the O-antigen part of A. actinomycetemcomitans LPS may mediate direct adhesion to abiotic surfaces [7]. Besides abiotic surfaces, A. actinomycetemcomitans LPS interacts with host molecules, such as human hemoglobin [129] and IL-8 [136], which may facilitate the iron acquisition and disturbance of host defense, respectively.
4.2. Sensing of Host Signal Molecules
A. actinomycetemcomitans is one of the human pathogens that is able to bind host cytokines, such as IL-1β, IL-8, and IL-6 [137,138], and internalize them [138,139], which leads to changes in the properties of biofilm, decreasing the metabolic activity [139], and changing the composition of the extracellular matrix [136,138]. Several potential bacterial proteins that may interact with human cytokines have been identified in A. actinomyctemcomitans, including intracellular ATP synthase subunit β [139], histone like DNA binding protein HU [139], and outer membrane proteins bacterial interleukin receptor I (BilRI) [138,140] and secretin channel HofQ [136]. The majority of these proteins have other functions in the bacterial cell related to metabolism, gene regulation, and uptake of nutrients and DNA for horizontal gene transfer, a character of so called “moonlighting” bacterial proteins [1]. Interactions with the above mentioned proteins may result in the observed uptake of cytokines, decreased metabolic activity and potentially, although not yet proved, also changes in the gene expression profile of A. actinomycetemcomitans. Both Gram-positive Staphylococcus aureus [141] and Gram-negatives Pseudomonas aeruginosa [142] and Neisseria meningitidis [143] are able to respond to cytokines, such as IL-1β, IFN-γ, IL-8, and TNF-α, by changing their virulence gene expression pattern.
Human cytokines are not the only host signalling molecules that A. actinomyctemcomitans is able to bind and sense. A. actinomyctemcomitans harbours the two-component system QseCB, which has originally been detected from enterohemorrhagic Escherichia coli EHEC [144]. In EHEC, QseCB senses either endogenous autoinducer-3 or host catecholamine hormones epinephrine/norepinephrine and induces the expression of Locus of Enterocyte Effacement (LEE) vital for the virulence of EHEC [145]. However, A. actinomycetemcomitans needs also iron, in addition to catecholamine hormone, to activate the QseC sensor kinase [146]. The QseCB signalling changes the gene expression pattern of A. actinomycetemcomitans, and especially the genes needed for anaerobic metabolisms are upregulated [146]. Moreover, QseC plays role in the biofilm formation in a flow cell in vitro model, since ΔqseC mutant strain forms significantly less biofilm in flow cells than the corresponding A. actinomyctemcomitans wild type and the complemented strains [147]. It is not known whether this impaired capacity to form biofilms also affects the virulence potential of A. actinomyctemcomitans in vivo. Yet, ΔqseC mutant strain causes less bone loss in murine model of periodontitis than the wild-type strain, suggesting a strong link between A. actinomycetemcomitans QseC and virulence [147].
5. Outer Membrane Vesicles
During the latest decades it has become apparent that membrane vesicles (MVs) are naturally shed during growth by many bacteria, archaea, and eukaryotes. Membrane vesicles, also known as “Type Zero secretion”, or referred to as outer membrane vesicles (OMVs) in Gram-negative organisms, serve as a general but relevant mechanism of antigen delivery, and are discharged by both commensal and pathogenic organisms in vivo and when infecting host cells in vitro [148,149]. Biologically active virulence factors such as CDT and OmpA can be transported into HeLa cells and human gingival fibroblasts via A. actinomycetemcomitans OMVs [150]. OMVs are also involved in the export of leukotoxin, peptidoglycan-associated lipoprotein (Pal), and the chaperonin GroEL to host cells [52,151,152,153]. Characterization of the OMV proteome of one A. actinomycetemcomitans clinical isolate using Matrix-Assisted Laser Desorption/Ionization Time of Flight-Mass Spectrometry (MALDI-TOF MS) revealed an array of additional tentative virulence-related proteins, including BilRI, Omp100, TdeA, and a ferritin-like protein [154,155]. This is in line with an OMV proteome exhibiting multiple offensive and defensive functions, such as drug targeting, iron acquisition, and immune evasion. A role of A. actinomycetemcomitans OMVs in serum resistance can be hypothesized based on observations that the vesicles could bind to the complement system regulator C4-binding protein in an OmpA-dependent manner [156]. Moreover, it has been shown that A. actinomycetemcomitans OMVs can transport small molecules such as those contributing to bone resorption, including LPS [157] and lipid A-associated proteins [158]. A. actinomycetemcomitans OMVs carry NOD1- and NOD2-active peptidoglycan, and upon vesicle internalization into non-phagocytic human cells such as gingival fibroblasts, the OMVs can act as an innate immunity trigger [9]. A. actinomycetemcomitans OMVs contain in addition nucleic acids [53], and recent evidence supports the concept that the OMVs can carry microRNA-sized small RNAs (msRNAs). These small RNAs might represent novel bacterial signaling molecules, which by means of OMVs can be transported into host cells to modulate the immune response [159]. A. actinomycetemcomitans OMVs appear to mainly internalize into host cells via clathrin-dependent endocytosis [9,160] but can also fuse with host cell membranes in a cholesterol-dependent manner [150]. Toxins associated with OMVs can function as adhesins in receptor-mediated endocytosis of vesicles [161], but such a role of CDT or leukotoxin appears less likely, as neither of the toxins are required for the uptake of OMVs into host cells [150,151]. Additionally, despite the evident localization of leukotoxin on the surface of A. actinomycetemcomitans OMVs, there is no requirement of the toxin receptor LFA1 for vesicle-mediated trafficking of LtxA into host cells [162].
6. Biofilm Interactions and Proteomic Regulations
6.1. Localization in Pocket and Tissue
As a microaerophic organism, A. actinomycetemcomitans is able to grow both supragingivally and subgingivally, corresponding to aerobic and anaerobic growth, respectively. As it can be detected at both locations, it has been postulated that the environment of supragingival plaque harbouring A. actinomycetemcomitans can act as a reservoir for the spread or reinfection of this bacterium of subgingivally [163]. When growing subgingivally, A. actinomycetemcomitans is reported to be detected in the loosely attached unattached plaque area in the middle pocket zone [164]. Earlier histopathological studies determined the prevalence and gingival localization of A. actinomycetemcomitans in periodontal lesions of juvenile periodontitis patients (earlier classification), using culture techniques on disrupted tissue or immunofluorescence microscopy on intact tissue. The former demonstrated the presence of A. actinomycetemcomitans in almost all diseased tissues examined, with evidence of microcolonies and single bacterial cells within the gingival connective tissue, as well as inside the phagocytic cells within the tissue [165]. The latter demonstrated an increase in A. actinomycetemcomitans colony-forming units, which correlated with its presence in the tissue and in the periodontal pocket [165]. In situ hybridization studies have detected A. actinomycetemcomitans in epithelial cells from the lining gingival crevice [166] or in close relationship with the polymorphonuclear infiltrate of the pocket [167]. By quantitative real-time PCR of gingival tissue lysates, it was shown that A. actinomycetemcomitans is present at a higher prevalence in tissues of younger patients with aggressive periodontitis as compared to chronic periodontitis or health [168].
6.2. Localization in Biofilms and Proteomic Interactions with Other Species
Studies on the localization of A. actimomycetemcomitans in biofilms largely comes from in vitro models. In supragingival and subgingival biofilms, A. actinomycetemcomitans does not appear to affect the number of the other species present and appears to form small, dense, and secluded cell clusters of its own species throughout the biofilm mass [169,170]. Yet, the lack of numeric changes on other species of the biofilm does exclude the possibility that A. actinomycetemcomitans exerts regulatory proteomic and metabolic changes in the biofilm, as discussed further.
The development of mass spectrometry (MS) technology made it possible to identify multiple proteins in a single run. Therefore, it is a useful tool to study how A. actinomycetemcomitans orchestrates proteomic changes in the context of biofilms. Using 2D gels, Llama-Palacios et al. discovered 87 protein spots differently expressed (1.5-fold, p < 0.05) between planktonic and mono-species biofilm cultures of A. actinomycetemcomitans [171]. Then, using MALDI-TOF MS, 13 upregulated proteins (from 24 proteins spots) and 37 downregulated proteins (from 50 spots) were identified. The upregulated proteins were mainly outer membrane proteins involved the immunologic process, whereas downregulated proteins were related to the metabolism, biosynthesis, and transport. This is consistent with the finding that mature biofilms display increased virulence [172] despite lower metabolic activity [173] as compared to planktonic culture.
Because oral biofilms occur as complex polymicrobial communities, the study of A. actinomycetemcomitans within multispecies biofilms is highly relevant. When integrated within a 10-species subgingival biofilm model, A. actinomycetemcomitans did not significantly impact the abundance of the other bacterial species, nor did it affect the biofilm structure, which is consistent with findings in a supragingival biofilm model. Using liquid chromatography–tandem mass spectrometry (LC-MS/MS), 3225 and 3352 microbial proteins were identified in multi-species biofilms in the absence or presence of A. actinomycetemcomitans, respectively [170]. Further investigations with label-free quantification (LFQ) method displayed 728 bacterial proteins and found 483 of them to be differentially regulated (2-fold, p < 0.05) among these two kinds of biofilms. Interestingly, the regulation trend for individual species was highly individual. For Prevotella intermedia, all quantified proteins were upregulated in the presence of A. actinomycetemcomitans, whereas the majority of the proteins were downregulated for Campylobacter rectus, Streptococcus anginosus, and P. gingivalis. These findings are well in line with the competing growth between P. gingivalis and A. actinomycetemcomitans, shown in a dual-species biofilm [174]. Furthermore, based on the GO analysis, A. actinomycetemcomitans appears to downregulate proteins with ferric iron binding functions and alter the metabolic rate for the overall biofilm.
To understand the effects of this A. actinomycetemcomitans-containing biofilms on host tissues, the biofilm model was introduced into a bioreactor-supervised 3D cell culture system, which consisted of epithelial and connective tissue structures to mimic the periodontium, as well as monocytes to stimulate the immune response [173]. As a result, S. anginosus, A. oris, V. dispar, C. rectus, and P. gingivalis were suppressed when present with the host tissue, while the tissue itself exhibited morphological, immunological, and proteomic changes. The numbers of A. actinomycetemcomitans in the biofilm were not reduced, but more of its proteins were expressed when co-cultured with the 3D (21 proteins) than the biofilm stand-alone (15 proteins) [173]. Yet, A. actinomycetemcomitans proteins only comprised a small fraction of all identified proteins in biofilm lysates (21 of 3363) and supernatants (one of 896).
Attachment to biotic surfaces or other biofilms enhances A. actinomyctemcomitans virulence properties. We have found that deletion of the gene hns, encoding a histone-like family of DNA-binding, nucleoid-structuring protein (H-NS), a global gene silencer [179], leads to a less piliated phenotype of A. actinomycetemcomitans and decreases its biofilm formation ability when cultured as mono-species biofilms [11]. LFQ showed that the majority (29) of the differentially expressed proteins (2-fold, p < 0.05) were upregulated in the hns mutant biofilm, supporting the role of H-NS as gene suppressor in A. actinomyctemcomitans. Notably, the affected proteins included virulence factors such as leukotoxin A and D (LtxA and LtxD). A similar repression activity of H-NS for virulence factors from other microbes was observed on hemolysin operons hlyCABD [180] and ehxCABD [181] in E. coli and rtxACBD in Vibrio cholerae [182]. Within multi-species biofilms, using the hns mutant there was a significant reduction of A. actinomycetemcomitans numbers, without affecting the number of other species. On the protein level, LFQ data suggested that many Fusobacterium nucleatum and Streptococcus oralis proteins were downregulated in biofilm harbouring the wild-type A. actinomyctemcomitans strain, as compared to its hns mutant counterpart, and these proteomic regulations may occur long before the corresponding bacterial growth is affected. Most of the regulated proteins were associated with peptide metabolic process and regulation of translation, supporting a protein-orchestrating role of H-NS in A. actinomycetemcomitans.
A literature summary of the proteomic findings on A. actinomycetemcomitans in single-species biofilms and multi-species biofilms is provided in Table 2 and Table 3, respectively.
Table 2.
Proteomic studies on single species A. actinomycetemcomitans.
Table 3.
Proteomic studies on multi-species biofilms including A. actinomycetemcomitans.
7. Horizontal Gene Transfer
A. actinomycetemcomitans strains can be divided into competent and non-competent ones, which refer to their ability to acquire new genes from up-taken extracellular DNA (eDNA) using homologous recombination. Competent strains may have some advantage of being able to uptake eDNA, which could be related to additional means to repair DNA damage, obtain nucleotides and possibly also novel genes [184]. Approximately 30% of clinical A. actinomycetemcomitans strains are naturally competent [185], leading to greater genetic diversity, whereas noncompetent strains are genetically stable and need to use other mechanisms, such as conjugative plasmids, for horizontal gene transfer (HGT) [186]. It is thought that the ancestral Pasteurellacean was naturally competent and that noncompetent lineages lost their ability to take up DNA due to various mutations in the competence gene locus [187]. This may explain the findings that noncompetent strains are more common among some serotype groups, such as serotype b and c [185]. The competence gene locus consists of regulatory sxy, DNA uptake–related comABCDE, pilABCD, comEAFE1, rec2, and transformation-related comM and urpA [186,188,189]. Noncompetent strains may contain nonsense mutations, or insertions in one or several of these genes, which makes the strain either unable to uptake eDNA and/or to incorporate it into the genome [186]. In addition to the above described gene locus, the CRISPR-cas system is also closely involved in natural competence, since the loss of CRISPR-cas system is connected to the loss of competence [186]. Thus, non-competent A. actinomycetemcomitans strains are more prone to HGT caused by plasmids and phages. However, in the non-competent strains, the maintained CRISPRs contains few spacers that most likely are used for chromosomal gene regulation, since they possess specificity for endogenous genes [186].
The expression on genes of competence locus are regulated by sxy (tfoX), of which levels in the cell is affected by various environmental factors, such as extracellular calcium ions [190] and the biofilm mode of growth [190]. Moreover, in addition to competence locus and CRISPR-cas system, the development of competence and expression levels of sxy are stimulated by cyclic AMP [191] and affected by the pga gene cluster [190], respectively. The genes in pga cluster are needed in the production of most abundant extracellular polysaccharide, N-acetyl-D-glucosamine, in A. actinomycetemcomitans biofilms.
Naturally competent A. actinomycetemcomitans strains recognize related eDNA, which is suitable to be taken up, using uptake signal sequence (USS). The Pasteurellaceae family has two types of USS, Hin and ApI, which contain distinctive consensus sequences of nine base pairs. A. actinomycetemcomitans has Hin type USS, consisting of A. actinomycetemcomitans GTGCGGT consensus sequence followed by AT-rich repeats [187,191]. This sequence is most likely recognized by the outer membrane proteins involved in the eDNA uptake. However, the recognizing protein has not yet been identified.
8. Conclusions
Aggregatibacter actinomycetemcomitans is a facultative anaerobic Gram-negative bacterium with the capacity to employ many virulence mechanisms closely associated to the pathogenesis of periodontitis. The variety of virulence properties of this bacterium contribute to the pathogenicity of this species, particularly with regard to early and rapidly progressive forms of periodontal disease. A. actinomycetemcomitans can be found in a large proportion of the human population, and due to the large genetic diversity of this species, several different genotypes or phenotypes with various virulence properties have emerged. Without doubt, individuals carrying A. actinomycetemcomitans genotypes with a proven enhanced leukotoxin production have a significantly increased risk to develop disease. More recent studies have identified suitable genes of this species, which can potentially be traced as markers for epidemiological population monitoring and utilization in individual risk assessment programs. Such bacterial virulence markers in periodontal disease may prove to be important tools in future strategies for personalized dentistry.
Author Contributions
Conceptualization, A.J., G.N.B., N.B., J.O., K.B., M.L., R.I., and T.M; Leukotoxin, A.J; Cytolethal distending toxin, G.N.B.; Outer membrane vesicles, M.L. and J.O.; Lipopolysaccharides, cytokine binding and horizontal gene transfer, R.I. and T.M.; Proteomic N.B. and K.B.; Data Curation, A.J., R.I., and J.O.; Writing—Original Draft Preparation, A.J. and G.N.B.; Writing—Review & Editing, A.J., G.N.B., N.B., J.O., K.B., M.L., R.I., and T.M.
Funding
This work was supported by institutional funds and by funds from the Swedish Research Council (N.B.; 2017-01198), TUA grants from the County Council of Västerbotten, Sweden (A.J.; 7003193), and the Academy of Finland (R.I.; 265609, 303781).
Acknowledgments
We thank the European Network for A. actinomycetemcomitans Research (https://projects.au.dk/aggregatibacter/) for encouraging us to prepare this review. In addition, we thank Rolf Claesson for the nice photos for Figure 1 and Sotirios Kalfas for excellent artwork in Figure 2.
Conflicts of Interest
The authors declare no conflict of interest.
References
- Henderson, B.; Ward, J.M.; Ready, D. Aggregatibacter (Actinobacillus) actinomycetemcomitans: A triple A* periodontopathogen? Periodontology 2000 2010, 54, 78–105. [Google Scholar] [CrossRef] [PubMed]
- Åberg, C.H.; Kelk, P.; Johansson, A. Aggregatibacter actinomycetemcomitans: Virulence of its leukotoxin and association with aggressive periodontitis. Virulence 2015, 6, 188–195. [Google Scholar] [CrossRef] [PubMed]
- Fine, D.H.; Patil, A.G.; Velusamy, S.K. Aggregatibacter actinomycetemcomitans (Aa) Under the Radar: Myths and Misunderstandings of Aa and Its Role in Aggressive Periodontitis. Front. Immunol. 2019, 10, 728. [Google Scholar] [CrossRef] [PubMed]
- Johansson, A. Aggregatibacter actinomycetemcomitans leukotoxin: A powerful tool with capacity to cause imbalance in the host inflammatory response. Toxins 2011, 3, 242–259. [Google Scholar] [CrossRef] [PubMed]
- Vega, B.A.; Belinka, B.A., Jr.; Kachlany, S.C. Aggregatibacter actinomycetemcomitans Leukotoxin (LtxA.; Leukothera((R))): Mechanisms of Action and Therapeutic Applications. Toxins 2019, 11, 489. [Google Scholar] [CrossRef]
- DiRienzo, J.M. Breaking the Gingival Epithelial Barrier: Role of the Aggregatibacter actinomycetemcomitans Cytolethal Distending Toxin in Oral Infectious Disease. Cells 2014, 3, 476–499. [Google Scholar] [CrossRef]
- Fujise, O.; Wang, Y.; Chen, W.; Chen, C. Adherence of Aggregatibacter actinomycetemcomitans via serotype-specific polysaccharide antigens in lipopolysaccharides. Oral Microbiol. Immunol. 2008, 23, 226–233. [Google Scholar] [CrossRef]
- Oscarsson, J.; Claesson, R.; Lindholm, M.; Höglund Åberg, C.; Johansson, A. Tools of Aggregatibacter actinomycetemcomitans to Evade the Host Response. J. Clin. Med. 2019, 8, 1079. [Google Scholar] [CrossRef]
- Thay, B.; Damm, A.; Kufer, T.A.; Wai, S.N.; Oscarsson, J. Aggregatibacter actinomycetemcomitans outer membrane vesicles are internalized in human host cells and trigger NOD1- and NOD2-dependent NF-kappaB activation. Infect. Immun. 2014, 82, 4034–4046. [Google Scholar] [CrossRef]
- Kittichotirat, W.; Bumgarner, R.E.; Chen, C. Evolutionary Divergence of Aggregatibacter actinomycetemcomitans. J. Dent. Res. 2016, 95, 94–101. [Google Scholar] [CrossRef]
- Bao, K.; Bostanci, N.; Thurnheer, T.; Grossmann, J.; Wolski, W.E.; Thay, B.; Belibasakis, G.N.; Oscarsson, J. Aggregatibacter actinomycetemcomitans H-NS promotes biofilm formation and alters protein dynamics of other species within a polymicrobial oral biofilm. NPJ Biofilms Microbiomes 2018, 4, 12. [Google Scholar] [CrossRef] [PubMed]
- Belibasakis, G.N.; Bostanci, N.; Marsh, P.D.; Zaura, E. Applications of the oral microbiome in personalized dentistry. Arch. Oral Biol. 2019, 104, 7–12. [Google Scholar] [CrossRef] [PubMed]
- Claesson, R.; Johansson, A.; Belibasakis, G.; Hanstrom, L.; Kalfas, S. Release and activation of matrix metalloproteinase 8 from human neutrophils triggered by the leukotoxin of Actinobacillus actinomycetemcomitans. J. Periodontal Res. 2002, 37, 353–359. [Google Scholar] [CrossRef] [PubMed]
- Johansson, A.; Claesson, R.; Hanstrom, L.; Sandstrom, G.; Kalfas, S. Polymorphonuclear leukocyte degranulation induced by leukotoxin from Actinobacillus actinomycetemcomitans. J. Periodontal Res. 2000, 35, 85–92. [Google Scholar] [CrossRef]
- Hirschfeld, J.; Roberts, H.M.; Chapple, I.L.; Parcina, M.; Jepsen, S.; Johansson, A.; Claesson, R. Effects of Aggregatibacter actinomycetemcomitans leukotoxin on neutrophil migration and extracellular trap formation. J. Oral Microbiol. 2016, 8, 33070. [Google Scholar] [CrossRef]
- Lopes, J.P.; Stylianou, M.; Backman, E.; Holmberg, S.; Jass, J.; Claesson, R.; Urban, C.F. Evasion of Immune Surveillance in Low Oxygen Environments Enhances Candida albicans Virulence. mBio 2018, 9. [Google Scholar] [CrossRef]
- Konig, M.F.; Abusleme, L.; Reinholdt, J.; Palmer, R.J.; Teles, R.P.; Sampson, K.; Rosen, A.; Nigrovic, P.A.; Sokolove, J.; Giles, J.T.; et al. Aggregatibacter actinomycetemcomitans-induced hypercitrullination links periodontal infection to autoimmunity in rheumatoid arthritis. Sci. Transl. Med. 2016, 8, 369ra176. [Google Scholar] [CrossRef]
- DiFranco, K.M.; Gupta, A.; Galusha, L.E.; Perez, J.; Nguyen, T.V.; Fineza, C.D.; Kachlany, S.C. Leukotoxin (Leukothera(R)) targets active leukocyte function antigen-1 (LFA-1) protein and triggers a lysosomal mediated cell death pathway. J. Biol. Chem. 2012, 287, 17618–17627. [Google Scholar] [CrossRef]
- Kelk, P.; Abd, H.; Claesson, R.; Sandstrom, G.; Sjostedt, A.; Johansson, A. Cellular and molecular response of human macrophages exposed to Aggregatibacter actinomycetemcomitans leukotoxin. Cell Death Dis. 2011, 2, e126. [Google Scholar] [CrossRef]
- Haubek, D.; Johansson, A. Pathogenicity of the highly leukotoxic JP2 clone of Aggregatibacter actinomycetemcomitans and its geographic dissemination and role in aggressive periodontitis. J. Oral Microbiol. 2014, 6. [Google Scholar] [CrossRef]
- Kononen, E.; Gursoy, M.; Gursoy, U.K. Periodontitis: A Multifaceted Disease of Tooth-Supporting Tissues. J. Clin. Med. 2019, 8, 1135. [Google Scholar] [CrossRef]
- Lally, E.T.; Golub, E.E.; Kieba, I.R. Identification and immunological characterization of the domain of Actinobacillus actinomycetemcomitans leukotoxin that determines its specificity for human target cells. J. Biol. Chem. 1994, 269, 31289–31295. [Google Scholar]
- Lally, E.T.; Kieba, I.R.; Sato, A.; Green, C.L.; Rosenbloom, J.; Korostoff, J.; Wang, J.F.; Shenker, B.J.; Ortlepp, S.; Robinson, M.K.; et al. RTX toxins recognize a beta2 integrin on the surface of human target cells. J. Biol. Chem. 1997, 272, 30463–30469. [Google Scholar] [CrossRef]
- Dileepan, T.; Kachlany, S.C.; Balashova, N.V.; Patel, J.; Maheswaran, S.K. Human CD18 is the functional receptor for Aggregatibacter actinomycetemcomitans leukotoxin. Infect. Immun. 2007, 75, 4851–4856. [Google Scholar] [CrossRef]
- Kieba, I.R.; Fong, K.P.; Tang, H.Y.; Hoffman, K.E.; Speicher, D.W.; Klickstein, L.B.; Lally, E.T. Aggregatibacter actinomycetemcomitans leukotoxin requires beta-sheets 1 and 2 of the human CD11a beta-propeller for cytotoxicity. Cell. Microbiol. 2007, 9, 2689–2699. [Google Scholar] [CrossRef]
- Ristow, L.C.; Tran, V.; Schwartz, K.J.; Pankratz, L.; Mehle, A.; Sauer, J.D.; Welch, R.A. The Extracellular Domain of the beta2 Integrin beta Subunit (CD18) Is Sufficient for Escherichia coli Hemolysin and Aggregatibacter actinomycetemcomitans Leukotoxin Cytotoxic Activity. mBio 2019, 10. [Google Scholar] [CrossRef]
- Lally, E.T.; Hill, R.B.; Kieba, I.R.; Korostoff, J. The interaction between RTX toxins and target cells. Trends Microbiol. 1999, 7, 356–361. [Google Scholar] [CrossRef]
- Kittichotirat, W.; Bumgarner, R.E.; Asikainen, S.; Chen, C. Identification of the pangenome and its components in 14 distinct Aggregatibacter actinomycetemcomitans strains by comparative genomic analysis. PLoS ONE 2011, 6, e22420. [Google Scholar] [CrossRef]
- Haubek, D. The highly leukotoxic JP2 clone of Aggregatibacter actinomycetemcomitans: Evolutionary aspects, epidemiology and etiological role in aggressive periodontitis. APMIS Suppl. 2010, 1–53. [Google Scholar] [CrossRef]
- Zambon, J.J. Actinobacillus actinomycetemcomitans in adult periodontitis. J. Periodontol. 1994, 65, 892–893. [Google Scholar] [CrossRef]
- Haubek, D.; Ennibi, O.K.; Poulsen, K.; Vaeth, M.; Poulsen, S.; Kilian, M. Risk of aggressive periodontitis in adolescent carriers of the JP2 clone of Aggregatibacter (Actinobacillus) actinomycetemcomitans in Morocco: A prospective longitudinal cohort study. Lancet 2008, 371, 237–242. [Google Scholar] [CrossRef]
- Höglund Åberg, C.; Kwamin, F.; Claesson, R.; Dahlen, G.; Johansson, A.; Haubek, D. Progression of attachment loss is strongly associated with presence of the JP2 genotype of Aggregatibacter actinomycetemcomitans: A prospective cohort study of a young adolescent population. J. Clin. Periodontol. 2014, 41, 232–241. [Google Scholar] [CrossRef]
- Brogan, J.M.; Lally, E.T.; Poulsen, K.; Kilian, M.; Demuth, D.R. Regulation of Actinobacillus actinomycetemcomitans leukotoxin expression: Analysis of the promoter regions of leukotoxic and minimally leukotoxic strains. Infect. Immun. 1994, 62, 501–508. [Google Scholar]
- Tsai, C.C.; Ho, Y.P.; Chou, Y.S.; Ho, K.Y.; Wu, Y.M.; Lin, Y.C. Aggregatibacter (Actinobacillus) actimycetemcomitans leukotoxin and human periodontitis—A historic review with emphasis on JP2. Kaohsiung J. Med. Sci. 2018, 34, 186–193. [Google Scholar] [CrossRef]
- Zambon, J.J.; Haraszthy, V.I.; Hariharan, G.; Lally, E.T.; Demuth, D.R. The Microbiology of Early-Onset Periodontitis: Association of Highly Toxic Actinobacillus actinomycetemcomitans Strains with Localized Juvenile Periodontitis. J. Periodontol. 1996, 67 (Suppl. 3S), 282–290. [Google Scholar] [CrossRef]
- Aberg, C.H.; Kwamin, F.; Claesson, R.; Johansson, A.; Haubek, D. Presence of JP2 and Non-JP2 Genotypes of Aggregatibacter actinomycetemcomitans and attachment loss in adolescents in Ghana. J. Periodontol. 2012, 83, 1520–1528. [Google Scholar] [CrossRef]
- Claesson, R.; Lagervall, M.; Hoglund-Aberg, C.; Johansson, A.; Haubek, D. Detection of the highly leucotoxic JP2 clone of Aggregatibacter actinomycetemcomitans in members of a Caucasian family living in Sweden. J. Clin. Periodontol. 2011, 38, 115–121. [Google Scholar] [CrossRef]
- Claesson, R.; Höglund-Åberg, C.; Haubek, D.; Johansson, A. Age-related prevalence and characteristics of Aggregatibacter actinomycetemcomitans in periodontitis patients living in Sweden. J. Oral Microbiol. 2017, 9, 1334504. [Google Scholar] [CrossRef]
- He, T.; Nishihara, T.; Demuth, D.R.; Ishikawa, I. A novel insertion sequence increases the expression of leukotoxicity in Actinobacillus actinomycetemcomitans clinical isolates. J. Periodontol. 1999, 70, 1261–1268. [Google Scholar] [CrossRef]
- Claesson, R.; Gudmundson, J.; Åberg, C.H.; Haubek, D.; Johansson, A. Detection of a 640-bp deletion in the Aggregatibacter actinomycetemcomitans leukotoxin promoter region in isolates from an adolescent of Ethiopian origin. J. Oral Microbiol. 2015, 7, 26974. [Google Scholar] [CrossRef]
- Höglund Åberg, C.; Haubek, D.; Kwamin, F.; Johansson, A.; Claesson, R. Leukotoxic activity of Aggregatibacter actinomycetemcomitans and periodontal attachment loss. PLoS ONE 2014, 9, e104095. [Google Scholar] [CrossRef] [PubMed]
- Johansson, A.; Claesson, R.; Höglund Åberg, C.; Haubek, D.; Lindholm, M.; Jasim, S.; Oscarsson, J. Genetic Profiling of Aggregatibacter actinomycetemcomitans Serotype B Isolated from Periodontitis Patients Living in Sweden. Pathogenes 2019, 8, 153. [Google Scholar] [CrossRef] [PubMed]
- Johansson, A.; Claesson, R.; Höglund Åberg, C.; Haubek, D.; Oscarsson, J. The cagE gene sequence as a diagnostic marker to identify JP2 and non-JP2 highly leukotoxic Aggregatibacter actinomycetemcomitans serotype b strains. J. Periodontal Res. 2017, 52, 903–912. [Google Scholar] [CrossRef] [PubMed]
- Gomez-Banuelos, E.; Mukherjee, A.; Darrah, E.; Andrade, F. Rheumatoid Arthritis-Associated Mechanisms of Porphyromonas gingivalis and Aggregatibacter actinomycetemcomitans. J. Clin. Med. 2019, 8, 1309. [Google Scholar] [CrossRef]
- Skals, M.; Greve, A.S.; Fagerberg, S.K.; Johnsen, N.; Christensen, M.G.; Praetorius, H.A. P2X1 receptor blockers reduce the number of circulating thrombocytes and the overall survival of urosepsis with haemolysin-producing Escherichia coli. Purinergic Signal. 2019, 15, 265–276. [Google Scholar] [CrossRef] [PubMed]
- Kachlany, S.C. Aggregatibacter actinomycetemcomitans leukotoxin: From threat to therapy. J. Dent. Res. 2010, 89, 561–570. [Google Scholar] [CrossRef]
- Linhartova, I.; Bumba, L.; Masin, J.; Basler, M.; Osicka, R.; Kamanova, J.; Prochazkova, K.; Adkins, I.; Hejnova-Holubova, J.; Sadilkova, L.; et al. RTX proteins: A highly diverse family secreted by a common mechanism. FEMS Microbiol. Rev. 2010, 34, 1076–1112. [Google Scholar] [CrossRef]
- Harding, C.M.; Pulido, M.R.; Di Venanzio, G.; Kinsella, R.L.; Webb, A.I.; Scott, N.E.; Pachon, J.; Feldman, M.F. Pathogenic Acinetobacter species have a functional type I secretion system and contact-dependent inhibition systems. J. Biol. Chem. 2017, 292, 9075–9087. [Google Scholar] [CrossRef]
- Crosby, J.A.; Kachlany, S.C. TdeA, a TolC-like protein required for toxin and drug export in Aggregatibacter (Actinobacillus) actinomycetemcomitans. Gene 2007, 388, 83–92. [Google Scholar] [CrossRef]
- Gallant, C.V.; Sedic, M.; Chicoine, E.A.; Ruiz, T.; Mintz, K.P. Membrane morphology and leukotoxin secretion are associated with a novel membrane protein of Aggregatibacter actinomycetemcomitans. J. Bacteriol. 2008, 190, 5972–5980. [Google Scholar] [CrossRef]
- Berthold, P.; Forti, D.; Kieba, I.R.; Rosenbloom, J.; Taichman, N.S.; Lally, E.T. Electron immunocytochemical localization of Actinobacillus actinomycetemcomitans leukotoxin. Oral Microbiol. Immunol. 1992, 7, 24–27. [Google Scholar] [CrossRef] [PubMed]
- Kato, S.; Kowashi, Y.; Demuth, D.R. Outer membrane-like vesicles secreted by Actinobacillus actinomycetemcomitans are enriched in leukotoxin. Microb. Pathog. 2002, 32, 1–13. [Google Scholar] [CrossRef] [PubMed]
- Ohta, H.; Kato, K.; Kokeguchi, S.; Hara, H.; Fukui, K.; Murayama, Y. Nuclease-sensitive binding of an Actinobacillus actinomycetemcomitans leukotoxin to the bacterial cell surface. Infect. Immun. 1991, 59, 4599–4605. [Google Scholar] [PubMed]
- Ohta, H.; Hara, H.; Fukui, K.; Kurihara, H.; Murayama, Y.; Kato, K. Association of Actinobacillus actinomycetemcomitans leukotoxin with nucleic acids on the bacterial cell surface. Infect. Immun. 1993, 61, 4878–4884. [Google Scholar]
- Johansson, A.; Hanstrom, L.; Kalfas, S. Inhibition of Actinobacillus actinomycetemcomitans leukotoxicity by bacteria from the subgingival flora. Oral Microbiol. Immunol. 2000, 15, 218–225. [Google Scholar] [CrossRef]
- Johansson, A.; Claesson, R.; Hanstrom, L.; Kalfas, S. Serum-mediated release of leukotoxin from the cell surface of the periodontal pathogen Actinobacillus actinomycetemcomitans. Eur. J. Oral Sci. 2003, 111, 209–215. [Google Scholar] [CrossRef]
- Balashova, N.V.; Diaz, R.; Balashov, S.V.; Crosby, J.A.; Kachlany, S.C. Regulation of Aggregatibacter (Actinobacillus) actinomycetemcomitans leukotoxin secretion by iron. J. Bacteriol. 2006, 188, 8658–8661. [Google Scholar] [CrossRef]
- Reinholdt, J.; Poulsen, K.; Brinkmann, C.R.; Hoffmann, S.V.; Stapulionis, R.; Enghild, J.J.; Jensen, U.B.; Boesen, T.; Vorup-Jensen, T. Monodisperse and LPS-free Aggregatibacter actinomycetemcomitans leukotoxin: Interactions with human beta2 integrins and erythrocytes. Biochim. Biophys. Acta 2013, 1834, 546–558. [Google Scholar] [CrossRef]
- Brage, M.; Holmlund, A.; Johansson, A. Humoral immune response to Aggregatibacter actinomycetemcomitans leukotoxin. J. Periodontal Res. 2011, 46, 170–175. [Google Scholar] [CrossRef]
- Johansson, A.; Buhlin, K.; Sorsa, T.; Pussinen, P.J. Systemic Aggregatibacter actinomycetemcomitans Leukotoxin-Neutralizing Antibodies in Periodontitis. J. Periodontol. 2017, 88, 122–129. [Google Scholar] [CrossRef]
- Johansson, A.; Claesson, R.; Belibasakis, G.; Makoveichuk, E.; Hanstrom, L.; Olivecrona, G.; Sandstrom, G.; Kalfas, S. Protease inhibitors, the responsible components for the serum-dependent enhancement of Actinobacillus actinomycetemcomitans leukotoxicity. Eur. J. Oral Sci. 2001, 109, 335–341. [Google Scholar] [CrossRef] [PubMed]
- Balashova, N.V.; Park, D.H.; Patel, J.K.; Figurski, D.H.; Kachlany, S.C. Interaction between leukotoxin and Cu, Zn superoxide dismutase in Aggregatibacter actinomycetemcomitans. Infect. Immun. 2007, 75, 4490–4497. [Google Scholar] [CrossRef] [PubMed]
- McArthur, W.P.; Tsai, C.C.; Baehni, P.C.; Genco, R.J.; Taichman, N.S. Leukotoxic effects of Actinobacillus actinomycetemcomitans. Modulation by serum components. J. Periodontal Res. 1981, 16, 159–170. [Google Scholar] [CrossRef] [PubMed]
- Johansson, A.; Claesson, R.; Belibasakis, G.; Makoveichuk, E.; Hanstrom, L.; Olivecrona, G.; Kalfas, S. Lack of lipoprotein-dependent effects on the cytotoxic interactions of Actinobacillus actinomycetemcomitans leukotoxin with human neutrophils. APMIS 2002, 110, 857–862. [Google Scholar] [CrossRef]
- Hritz, M.; Fisher, E.; Demuth, D.R. Differential regulation of the leukotoxin operon in highly leukotoxic and minimally leukotoxic strains of Actinobacillus actinomycetemcomitans. Infect. Immun. 1996, 64, 2724–2729. [Google Scholar]
- Tsai, C.C.; McArthur, W.P.; Baehni, P.C.; Hammond, B.F.; Taichman, N.S. Extraction and partial characterization of a leukotoxin from a plaque-derived Gram-negative microorganism. Infect. Immun. 1979, 25, 427–439. [Google Scholar]
- Zambon, J.J.; DeLuca, C.; Slots, J.; Genco, R.J. Studies of leukotoxin from Actinobacillus actinomycetemcomitans using the promyelocytic HL-60 cell line. Infect. Immun. 1983, 40, 205–212. [Google Scholar]
- Sampathkumar, V.; Velusamy, S.K.; Godboley, D.; Fine, D.H. Increased leukotoxin production: Characterization of 100 base pairs within the 530 base pair leukotoxin promoter region of Aggregatibacter actinomycetemcomitans. Sci. Rep. 2017, 7, 1887. [Google Scholar] [CrossRef]
- Kelk, P.; Claesson, R.; Chen, C.; Sjostedt, A.; Johansson, A. IL-1beta secretion induced by Aggregatibacter (Actinobacillus) actinomycetemcomitans is mainly caused by the leukotoxin. Int. J. Med. Microbiol. IJMM 2008, 298, 529–541. [Google Scholar] [CrossRef]
- Umeda, J.E.; Longo, P.L.; Simionato, M.R.; Mayer, M.P. Differential transcription of virulence genes in Aggregatibacter actinomycetemcomitans serotypes. J. Oral Microbiol. 2013, 5. [Google Scholar] [CrossRef]
- Lara-Tejero, M.; Galan, J.E. A bacterial toxin that controls cell cycle progression as a deoxyribonuclease I-like protein. Science 2000, 290, 354–357. [Google Scholar] [CrossRef] [PubMed]
- Boesze-Battaglia, K.; Besack, D.; McKay, T.; Zekavat, A.; Otis, L.; Jordan-Sciutto, K.; Shenker, B.J. Cholesterol-rich membrane microdomains mediate cell cycle arrest induced by Actinobacillus actinomycetemcomitans cytolethal-distending toxin. Cell Microbiol. 2006, 8, 823–836. [Google Scholar] [CrossRef] [PubMed]
- Boesze-Battaglia, K.; Alexander, D.; Dlakic, M.; Shenker, B.J. A Journey of Cytolethal Distending Toxins through Cell Membranes. Front. Cell. Infect. Microbiol. 2016, 6, 81. [Google Scholar] [CrossRef] [PubMed]
- Fais, T.; Delmas, J.; Serres, A.; Bonnet, R.; Dalmasso, G. Impact of CDT Toxin on Human Diseases. Toxins 2016, 8, 220. [Google Scholar] [CrossRef] [PubMed]
- Belibasakis, G.; Johansson, A.; Wang, Y.; Claesson, R.; Chen, C.; Asikainen, S.; Kalfas, S. Inhibited proliferation of human periodontal ligament cells and gingival fibroblasts by Actinobacillus actinomycetemcomitans: Involvement of the cytolethal distending toxin. Eur. J. Oral Sci. 2002, 110, 366–373. [Google Scholar] [CrossRef]
- Belibasakis, G.N.; Mattsson, A.; Wang, Y.; Chen, C.; Johansson, A. Cell cycle arrest of human gingival fibroblasts and periodontal ligament cells by Actinobacillus actinomycetemcomitans: Involvement of the cytolethal distending toxin. APMIS 2004, 112, 674–685. [Google Scholar] [CrossRef]
- Kang, P.; Korostoff, J.; Volgina, A.; Grzesik, W.; DiRienzo, J.M. Differential effect of the cytolethal distending toxin of Actinobacillus actinomycetemcomitans on co-cultures of human oral cells. J. Med. Microbiol. 2005, 54, 785–794. [Google Scholar] [CrossRef]
- Alaoui-El-Azher, M.; Mans, J.J.; Baker, H.V.; Chen, C.; Progulske-Fox, A.; Lamont, R.J.; Handfield, M. Role of the ATM-checkpoint kinase 2 pathway in CDT-mediated apoptosis of gingival epithelial cells. PLoS ONE 2010, 5, e11714. [Google Scholar] [CrossRef]
- Damek-Poprawa, M.; Haris, M.; Volgina, A.; Korostoff, J.; DiRienzo, J.M. Cytolethal distending toxin damages the oral epithelium of gingival explants. J. Dent. Res. 2011, 90, 874–879. [Google Scholar] [CrossRef]
- Kanno, F.; Korostoff, J.; Volgina, A.; DiRienzo, J.M. Resistance of human periodontal ligament fibroblasts to the cytolethal distending toxin of Actinobacillus actinomycetemcomitans. J. Periodontol. 2005, 76, 1189–1201. [Google Scholar] [CrossRef]
- Damek-Poprawa, M.; Korostoff, J.; Gill, R.; DiRienzo, J.M. Cell junction remodeling in gingival tissue exposed to a microbial toxin. J. Dent. Res. 2013, 92, 518–523. [Google Scholar] [CrossRef] [PubMed]
- Ohara, M.; Miyauchi, M.; Tsuruda, K.; Takata, T.; Sugai, M. Topical application of Aggregatibacter actinomycetemcomitans cytolethal distending toxin induces cell cycle arrest in the rat gingival epithelium in vivo. J. Periodontal Res. 2011, 46, 389–395. [Google Scholar] [CrossRef] [PubMed]
- Shenker, B.J.; McKay, T.; Datar, S.; Miller, M.; Chowhan, R.; Demuth, D. Actinobacillus actinomycetemcomitans immunosuppressive protein is a member of the family of cytolethal distending toxins capable of causing a G2 arrest in human T cells. J. Immunol. 1999, 162, 4773–4780. [Google Scholar] [PubMed]
- Sato, T.; Koseki, T.; Yamato, K.; Saiki, K.; Konishi, K.; Yoshikawa, M.; Ishikawa, I.; Nishihara, T. p53-independent expression of p21(CIP1/WAF1) in plasmacytic cells during G(2) cell cycle arrest induced by Actinobacillus actinomycetemcomitans cytolethal distending toxin. Infect. Immun. 2002, 70, 528–534. [Google Scholar] [CrossRef] [PubMed]
- Akifusa, S.; Poole, S.; Lewthwaite, J.; Henderson, B.; Nair, S.P. Recombinant Actinobacillus actinomycetemcomitans cytolethal distending toxin proteins are required to interact to inhibit human cell cycle progression and to stimulate human leukocyte cytokine synthesis. Infect. Immun. 2001, 69, 5925–5930. [Google Scholar] [CrossRef] [PubMed]
- Belibasakis, G.N.; Bostanci, N. Inflammatory and bone remodeling responses to the cytolethal distending toxins. Cells 2014, 3, 236–246. [Google Scholar] [CrossRef]
- Oscarsson, J.; Karched, M.; Thay, B.; Chen, C.; Asikainen, S. Proinflammatory effect in whole blood by free soluble bacterial components released from planktonic and biofilm cells. BMC Microbiol. 2008, 8, 206. [Google Scholar] [CrossRef]
- Belibasakis, G.N.; Johansson, A. Aggregatibacter actinomycetemcomitans targets NLRP3 and NLRP6 inflammasome expression in human mononuclear leukocytes. Cytokine 2012, 59, 124–130. [Google Scholar] [CrossRef]
- Belibasakis, G.N.; Bostanci, N. The RANKL-OPG system in clinical periodontology. J. Clin. Periodontol. 2012, 39, 239–248. [Google Scholar] [CrossRef]
- Belibasakis, G.N.; Johansson, A.; Wang, Y.; Chen, C.; Kalfas, S.; Lerner, U.H. The cytolethal distending toxin induces receptor activator of NF-kappaB ligand expression in human gingival fibroblasts and periodontal ligament cells. Infect. Immun. 2005, 73, 342–351. [Google Scholar] [CrossRef]
- Belibasakis, G.N.; Johansson, A.; Wang, Y.; Chen, C.; Lagergård, T.; Kalfas, S.; Lerner, U.H. Cytokine responses of human gingival fibroblasts to Actinobacillus actinomycetemcomitans cytolethal distending toxin. Cytokine 2005, 30, 56–63. [Google Scholar] [CrossRef] [PubMed]
- Belibasakis, G.N.; Brage, M.; Lagergard, T.; Johansson, A. Cytolethal distending toxin upregulates RANKL expression in Jurkat T-cells. APMIS 2008, 116, 499–506. [Google Scholar] [CrossRef] [PubMed]
- Kawamoto, D.; Ando-Suguimoto, E.S.; Bueno-Silva, B.; DiRienzo, J.M.; Mayer, M.P. Alteration of Homeostasis in Pre-osteoclasts Induced by Aggregatibacter actinomycetemcomitans CDT. Front. Cell. Infect. Microbiol. 2016, 6, 33. [Google Scholar] [CrossRef] [PubMed]
- Kaplan, J.B.; Perry, M.B.; MacLean, L.L.; Furgang, D.; Wilson, M.E.; Fine, D.H. Structural and genetic analyses of O polysaccharide from Actinobacillus actinomycetemcomitans serotype f. Infect. Immun. 2001, 69, 5375–5384. [Google Scholar] [CrossRef]
- Perry, M.B.; MacLean, L.M.; Brisson, J.R.; Wilson, M.E. Structures of the antigenic O-polysaccharides of lipopolysaccharides produced by Actinobacillus actinomycetemcomitans serotypes a, c, d and e. Eur. J. Biochem. 1996, 242, 682–688. [Google Scholar] [CrossRef]
- Perry, M.B.; MacLean, L.L.; Gmur, R.; Wilson, M.E. Characterization of the O-polysaccharide structure of lipopolysaccharide from Actinobacillus actinomycetemcomitans serotype b. Infect. Immun. 1996, 64, 1215–1219. [Google Scholar]
- Masoud, H.; Weintraub, S.T.; Wang, R.; Cotter, R.; Holt, S.C. Investigation of the structure of lipid A from Actinobacillus actinomycetemcomitans strain Y4 and human clinical isolate PO 1021-7. Eur. J. Biochem. 1991, 200, 775–781. [Google Scholar] [CrossRef]
- Suzuki, N.; Nakano, Y.; Yoshida, Y.; Ikeda, D.; Koga, T. Identification of Actinobacillus actinomycetemcomitans serotypes by multiplex PCR. J. Clin. Microbiol. 2001, 39, 2002–2005. [Google Scholar] [CrossRef]
- Brondz, I.; Olsen, I. Chemical differences in lipopolysaccharides from Actinobacillus (Haemophilus) actinomycetemcomitans and Haemophilus aphrophilus: Clues to differences in periodontopathogenic potential and taxonomic distinction. Infect. Immun. 1989, 57, 3106–3109. [Google Scholar]
- Brondz, I.; Olsen, I. Determination of acids in whole lipopolysaccharide and in free lipid A from Actinobacillus actinomycetemcomitans and Haemophilus aphrophilus. J. Chromatogr. 1984, 308, 19–29. [Google Scholar] [CrossRef]
- Bryn, K.; Jantzen, E. Analysis of lipopolysaccharides by methanolysis, trifluoroacetylation, and gas chromatography on a fused-silica capillary column. J. Chromatogr. 1982, 240, 405–413. [Google Scholar] [CrossRef]
- Kiley, P.; Holt, S.C. Characterization of the lipopolysaccharide from Actinobacillus actinomycetemcomitans Y4 and N27. Infect. Immun. 1980, 30, 862–873. [Google Scholar] [PubMed]
- Schneider, B.; Weigel, W.; Sztukowska, M.; Demuth, D.R. Identification and functional characterization of type II toxin/antitoxin systems in Aggregatibacter actinomycetemcomitans. Mol. Oral Microbiol. 2018, 33, 224–233. [Google Scholar] [CrossRef] [PubMed]
- Sreenivasan, P.K.; Meyer, D.H.; Fives-Taylor, P.M. Factors influencing the growth and viability of Actinobacillus actinomycetemcomitans. Oral Microbiol. Immunol. 1993, 8, 361–369. [Google Scholar] [CrossRef] [PubMed]
- Brondz, I.; Olsen, I. Differentiation between Actinobacillus actinomycetemcomitans and Haemophilus aphrophilus based on carbohydrates in lipopolysaccharide. J. Chromatogr. 1984, 310, 261–272. [Google Scholar] [CrossRef]
- Brondz, I.; Olsen, I. Multivariate analyses of carbohydrate data from lipopolysaccharides of Actinobacillus (Haemophilus) actinomycetemcomitans, Haemophilus aphrophilus, and Haemophilus paraphrophilus. Int. J. Syst. Bacteriol. 1990, 40, 405–408. [Google Scholar] [CrossRef]
- Patil, C.; Rossa, C., Jr.; Kirkwood, K.L. Actinobacillus actinomycetemcomitans lipopolysaccharide induces interleukin-6 expression through multiple mitogen-activated protein kinase pathways in periodontal ligament fibroblasts. Oral Microbiol. Immunol. 2006, 21, 392–398. [Google Scholar] [CrossRef]
- Rogers, J.E.; Li, F.; Coatney, D.D.; Rossa, C.; Bronson, P.; Krieder, J.M.; Giannobile, W.V.; Kirkwood, K.L. Actinobacillus actinomycetemcomitans lipopolysaccharide-mediated experimental bone loss model for aggressive periodontitis. J. Periodontol. 2007, 78, 550–558. [Google Scholar] [CrossRef]
- Morishita, M.; Ariyoshi, W.; Okinaga, T.; Usui, M.; Nakashima, K.; Nishihara, T. A. actinomycetemcomitans LPS enhances foam cell formation induced by LDL. J. Dent. Res. 2013, 92, 241–246. [Google Scholar] [CrossRef]
- Park, O.J.; Cho, M.K.; Yun, C.H.; Han, S.H. Lipopolysaccharide of Aggregatibacter actinomycetemcomitans induces the expression of chemokines MCP-1, MIP-1alpha, and IP-10 via similar but distinct signaling pathways in murine macrophages. Immunobiology 2015, 220, 1067–1074. [Google Scholar] [CrossRef]
- Valerio, M.S.; Herbert, B.A.; Basilakos, D.S.; Browne, C.; Yu, H.; Kirkwood, K.L. Critical role of MKP-1 in lipopolysaccharide-induced osteoclast formation through CXCL1 and CXCL2. Cytokine 2015, 71, 71–80. [Google Scholar] [CrossRef] [PubMed]
- Tao, L.; Reese, T.A. Making Mouse Models That Reflect Human Immune Responses. Trends Immunol. 2017, 38, 181–193. [Google Scholar] [CrossRef] [PubMed]
- Suga, T.; Mitani, A.; Mogi, M.; Kikuchi, T.; Fujimura, T.; Takeda, H.; Hishikawa, T.; Yamamoto, G.; Hayashi, J.; Ishihara, Y.; et al. Aggregatibacter actinomycetemcomitans lipopolysaccharide stimulated epithelial cells produce interleukin-15 that regulates T cell activation. Arch. Oral Biol. 2013, 58, 1541–1548. [Google Scholar] [CrossRef]
- Takahashi, N.; Kobayashi, M.; Takaki, T.; Takano, K.; Miyata, M.; Okamatsu, Y.; Hasegawa, K.; Nishihara, T.; Yamamoto, M. Actinobacillus actinomycetemcomitans lipopolysaccharide stimulates collagen phagocytosis by human gingival fibroblasts. Oral Microbiol. Immunol. 2008, 23, 259–264. [Google Scholar] [CrossRef]
- Xiao, Y.; Bunn, C.L.; Bartold, P.M. Effect of lipopolysaccharide from periodontal pathogens on the production of tissue plasminogen activator and plasminogen activator inhibitor 2 by human gingival fibroblasts. J. Periodontal Res. 2001, 36, 25–31. [Google Scholar] [CrossRef] [PubMed]
- Naqvi, A.R.; Fordham, J.B.; Khan, A.; Nares, S. MicroRNAs responsive to Aggregatibacter actinomycetemcomitans and Porphyromonas gingivalis LPS modulate expression of genes regulating innate immunity in human macrophages. Innate Immun. 2014, 20, 540–551. [Google Scholar] [CrossRef] [PubMed]
- Taganov, K.D.; Boldin, M.P.; Chang, K.J.; Baltimore, D. NF-kappaB-dependent induction of microRNA miR-146, an inhibitor targeted to signaling proteins of innate immune responses. Proc. Natl. Acad. Sci. USA 2006, 103, 12481–12486. [Google Scholar] [CrossRef]
- Gocek, E.; Wang, X.; Liu, X.; Liu, C.G.; Studzinski, G.P. MicroRNA-32 upregulation by 1,25-dihydroxyvitamin D3 in human myeloid leukemia cells leads to Bim targeting and inhibition of AraC-induced apoptosis. Cancer Res. 2011, 71, 6230–6239. [Google Scholar] [CrossRef]
- Sosroseno, W.; Bird, P.S.; Seymour, G.J. Nitric oxide production by a human osteoblast cell line stimulated with Aggregatibacter actinomycetemcomitans lipopolysaccharide. Oral Microbiol. Immunol. 2009, 24, 50–55. [Google Scholar] [CrossRef]
- Ralston, S.H.; Grabowski, P.S. Mechanisms of cytokine induced bone resorption: Role of nitric oxide, cyclic guanosine monophosphate, and prostaglandins. Bone 1996, 19, 29–33. [Google Scholar] [CrossRef]
- Pollanen, M.T.; Salonen, J.I.; Grenier, D.; Uitto, V.J. Epithelial cell response to challenge of bacterial lipoteichoic acids and lipopolysaccharides in vitro. J. Med. Microbiol. 2000, 49, 245–252. [Google Scholar] [CrossRef] [PubMed]
- Ohguchi, Y.; Ishihara, Y.; Ohguchi, M.; Koide, M.; Shirozu, N.; Naganawa, T.; Nishihara, T.; Noguchi, T. Capsular polysaccharide from Actinobacillus actinomycetemcomitans inhibits IL-6 and IL-8 production in human gingival fibroblast. J. Periodontal Res. 2003, 38, 191–197. [Google Scholar] [CrossRef] [PubMed]
- Kikuchi, T.; Hahn, C.L.; Tanaka, S.; Barbour, S.E.; Schenkein, H.A.; Tew, J.G. Dendritic cells stimulated with Actinobacillus actinomycetemcomitans elicit rapid gamma interferon responses by natural killer cells. Infect. Immun. 2004, 72, 5089–5096. [Google Scholar] [CrossRef] [PubMed][Green Version]
- Diaz-Zuniga, J.; Yanez, J.P.; Alvarez, C.; Melgar-Rodriguez, S.; Hernandez, M.; Sanz, M.; Vernal, R. Serotype-dependent response of human dendritic cells stimulated with Aggregatibacter actinomycetemcomitans. J. Clin. Periodontol. 2014, 41, 242–251. [Google Scholar] [CrossRef] [PubMed]
- Aida, Y.; Kukita, T.; Takada, H.; Maeda, K.; Pabst, M.J. Lipopolysaccharides from periodontal pathogens prime neutrophils for enhanced respiratory burst: Differential effect of a synthetic lipid a precursor IVA (LA-14-PP). J. Periodontal Res. 1995, 30, 116–123. [Google Scholar] [CrossRef]
- Yoshimura, A.; Hara, Y.; Kaneko, T.; Kato, I. Secretion of IL-1 beta, TNF-alpha, IL-8 and IL-1ra by human polymorphonuclear leukocytes in response to lipopolysaccharides from periodontopathic bacteria. J. Periodontal Res. 1997, 32, 279–286. [Google Scholar] [CrossRef]
- Schytte Blix, I.J.; Helgeland, K.; Hvattum, E.; Lyberg, T. Lipopolysaccharide from Actinobacillus actinomycetemcomitans stimulates production of interleukin-1beta, tumor necrosis factor-alpha, interleukin-6 and interleukin-1 receptor antagonist in human whole blood. J. Periodontal Res. 1999, 34, 34–40. [Google Scholar] [CrossRef]
- Blix, I.J.; Helgeland, K.; Kahler, H.; Lyberg, T. LPS from Actinobacillus actinomycetemcomitans and the expression of beta2 integrins and L-selectin in an ex vivo human whole blood system. Eur. J. Oral Sci. 1999, 107, 14–20. [Google Scholar] [CrossRef]
- Grenier, D.; Leduc, A.; Mayrand, D. Interaction between Actinobacillus actinomycetemcomitans lipopolysaccharides and human hemoglobin. FEMS Microbiol. Lett. 1997, 151, 77–81. [Google Scholar] [CrossRef][Green Version]
- Ahlstrand, T.; Kovesjoki, L.; Maula, T.; Oscarsson, J.; Ihalin, R. Aggregatibacter actinomycetemcomitans LPS binds human interleukin-8. J. Oral Microbiol. 2019, 11, 1549931. [Google Scholar] [CrossRef]
- Papapanou, P.N.; Sanz, M.; Buduneli, N.; Dietrich, T.; Feres, M.; Fine, D.H.; Flemmig, T.F.; Garcia, R.; Giannobile, W.V.; Graziani, F.; et al. Periodontitis: Consensus report of workgroup 2 of the 2017 World Workshop on the Classification of Periodontal and Peri-Implant Diseases and Conditions. J. Clin. Periodontol. 2018, 45 (Suppl. 20), S162–S170. [Google Scholar] [CrossRef]
- Barbour, S.E.; Ishihara, Y.; Fakher, M.; Al-Darmaki, S.; Caven, T.H.; Shelburne, C.P.; Best, A.M.; Schenkein, H.A.; Tew, J.G. Monocyte differentiation in localized juvenile periodontitis is skewed toward the dendritic cell phenotype. Infect. Immun. 2002, 70, 2780–2786. [Google Scholar] [CrossRef] [PubMed][Green Version]
- Diaz-Zuniga, J.; Melgar-Rodriguez, S.; Alvarez, C.; Monasterio, G.; Benitez, A.; Ciuchi, P.; Diaz, C.; Mardones, J.; Escobar, A.; Sanz, M.; et al. T-lymphocyte phenotype and function triggered by Aggregatibacter actinomycetemcomitans is serotype-dependent. J. Periodontal Res. 2015, 50, 824–835. [Google Scholar] [CrossRef] [PubMed]
- Nicu, E.A.; Loos, B.G. Polymorphonuclear neutrophils in periodontitis and their possible modulation as a therapeutic approach. Periodontology 2000 2016, 71, 140–163. [Google Scholar] [CrossRef] [PubMed]
- Tang, G.; Kawai, T.; Komatsuzawa, H.; Mintz, K.P. Lipopolysaccharides mediate leukotoxin secretion in Aggregatibacter actinomycetemcomitans. Mol. Oral Microbiol. 2012, 27, 70–82. [Google Scholar] [CrossRef]
- Ahlstrand, T.; Torittu, A.; Elovaara, H.; Valimaa, H.; Pollanen, M.T.; Kasvandik, S.; Hogbom, M.; Ihalin, R. Interactions between the Aggregatibacter actinomycetemcomitans secretin HofQ and host cytokines indicate a link between natural competence and interleukin-8 uptake. Virulence 2018, 9, 1205–1223. [Google Scholar] [CrossRef]
- Paino, A.; Tuominen, H.; Jaaskelainen, M.; Alanko, J.; Nuutila, J.; Asikainen, S.E.; Pelliniemi, L.J.; Pollanen, M.T.; Chen, C.; Ihalin, R. Trimeric form of intracellular ATP synthase subunit beta of Aggregatibacter actinomycetemcomitans binds human interleukin-1beta. PLoS ONE 2011, 6, e18929. [Google Scholar] [CrossRef]
- Ahlstrand, T.; Tuominen, H.; Beklen, A.; Torittu, A.; Oscarsson, J.; Sormunen, R.; Pollanen, M.T.; Permi, P.; Ihalin, R. A novel intrinsically disordered outer membrane lipoprotein of Aggregatibacter actinomycetemcomitans binds various cytokines and plays a role in biofilm response to interleukin-1beta and interleukin-8. Virulence 2017, 8, 115–134. [Google Scholar] [CrossRef]
- Paino, A.; Lohermaa, E.; Sormunen, R.; Tuominen, H.; Korhonen, J.; Pollanen, M.T.; Ihalin, R. Interleukin-1beta is internalised by viable Aggregatibacter actinomycetemcomitans biofilm and locates to the outer edges of nucleoids. Cytokine 2012, 60, 565–574. [Google Scholar] [CrossRef]
- Paino, A.; Ahlstrand, T.; Nuutila, J.; Navickaite, I.; Lahti, M.; Tuominen, H.; Valimaa, H.; Lamminmaki, U.; Pollanen, M.T.; Ihalin, R. Identification of a novel bacterial outer membrane interleukin-1Beta-binding protein from Aggregatibacter actinomycetemcomitans. PLoS ONE 2013, 8, e70509. [Google Scholar] [CrossRef]
- Kanangat, S.; Postlethwaite, A.; Cholera, S.; Williams, L.; Schaberg, D. Modulation of virulence gene expression in Staphylococcus aureus by interleukin-1beta: Novel implications in bacterial pathogenesis. Microbes Infect. 2007, 9, 408–415. [Google Scholar] [CrossRef] [PubMed]
- Wu, M.; Guina, T.; Brittnacher, M.; Nguyen, H.; Eng, J.; Miller, S.I. The Pseudomonas aeruginosa proteome during anaerobic growth. J. Bacteriol. 2005, 187, 8185–8190. [Google Scholar] [CrossRef] [PubMed]
- Mahdavi, J.; Royer, P.J.; Sjolinder, H.S.; Azimi, S.; Self, T.; Stoof, J.; Wheldon, L.M.; Brannstrom, K.; Wilson, R.; Moreton, J.; et al. Pro-inflammatory cytokines can act as intracellular modulators of commensal bacterial virulence. Open Biol. 2013, 3, 130048. [Google Scholar] [CrossRef] [PubMed]
- Sperandio, V.; Torres, A.G.; Kaper, J.B. Quorum sensing Escherichia coli regulators B and C (QseBC): A novel two-component regulatory system involved in the regulation of flagella and motility by quorum sensing in E. coli. Mol. Microbiol. 2002, 43, 809–821. [Google Scholar] [CrossRef] [PubMed]
- Moreira, C.G.; Sperandio, V. The Epinephrine/Norepinephrine/Autoinducer-3 Interkingdom Signaling System in Escherichia coli O157:H7. Adv. Exp. Med. Biol. 2016, 874, 247–261. [Google Scholar] [CrossRef] [PubMed]
- Weigel, W.A.; Demuth, D.R.; Torres-Escobar, A.; Juarez-Rodriguez, M.D. Aggregatibacter actinomycetemcomitans QseBC is activated by catecholamines and iron and regulates genes encoding proteins associated with anaerobic respiration and metabolism. Mol. Oral Microbiol. 2015, 30, 384–398. [Google Scholar] [CrossRef]
- Novak, E.A.; Shao, H.; Daep, C.A.; Demuth, D.R. Autoinducer-2 and QseC control biofilm formation and in vivo virulence of Aggregatibacter actinomycetemcomitans. Infect. Immun. 2010, 78, 2919–2926. [Google Scholar] [CrossRef]
- Deatherage, B.L.; Cookson, B.T. Membrane vesicle release in bacteria, eukaryotes, and archaea: A conserved yet underappreciated aspect of microbial life. Infect. Immun. 2012, 80, 1948–1957. [Google Scholar] [CrossRef]
- Uhlin, B.E.; Oscarsson, J.; Wai, S.N. Haemolysins. In Pathogenic Escherichia Coli: Molecular and Cellular Microbiology; Morabito, S., Ed.; Caister Academic Press: Norfolk, UK, 2014; pp. 161–180. [Google Scholar]
- Rompikuntal, P.K.; Thay, B.; Khan, M.K.; Alanko, J.; Penttinen, A.M.; Asikainen, S.; Wai, S.N.; Oscarsson, J. Perinuclear localization of internalized outer membrane vesicles carrying active cytolethal distending toxin from Aggregatibacter actinomycetemcomitans. Infect. Immun. 2012, 80, 31–42. [Google Scholar] [CrossRef]
- Demuth, D.R.; James, D.; Kowashi, Y.; Kato, S. Interaction of Actinobacillus actinomycetemcomitans outer membrane vesicles with HL60 cells does not require leukotoxin. Cell. Microbiol. 2003, 5, 111–121. [Google Scholar] [CrossRef]
- Goulhen, F.; Hafezi, A.; Uitto, V.J.; Hinode, D.; Nakamura, R.; Grenier, D.; Mayrand, D. Subcellular localization and cytotoxic activity of the GroEL-like protein isolated from Actinobacillus actinomycetemcomitans. Infect. Immun. 1998, 66, 5307–5313. [Google Scholar] [PubMed]
- Karched, M.; Ihalin, R.; Eneslätt, K.; Zhong, D.; Oscarsson, J.; Wai, S.N.; Chen, C.; Asikainen, S.E. Vesicle-independent extracellular release of a proinflammatory outer membrane lipoprotein in free-soluble form. BMC Microbiol. 2008, 8, 18. [Google Scholar] [CrossRef] [PubMed]
- Kieselbach, T.; Zijnge, V.; Granström, E.; Oscarsson, J. Proteomics of Aggregatibacter actinomycetemcomitans Outer Membrane Vesicles. PLoS ONE 2015, 10, e0138591. [Google Scholar] [CrossRef] [PubMed]
- Kieselbach, T.; Oscarsson, J. Dataset of the proteome of purified outer membrane vesicles from the human pathogen Aggregatibacter actinomycetemcomintans. Data Brief 2017, 10, 426–431. [Google Scholar] [CrossRef] [PubMed]
- Rochester, D.F. Does respiratory muscle rest relieve fatigue or incipient fatigue? Am. Rev. Respir. Dis. 1988, 138, 516–517. [Google Scholar] [CrossRef]
- Iino, Y.; Hopps, R.M. The bone-resorbing activities in tissue culture of lipopolysaccharides from the bacteria Actinobacillus actinomycetemcomitans, Bacteroides gingivalis and Capnocytophaga ochracea isolated from human mouths. Arch. Oral Biol. 1984, 29, 59–63. [Google Scholar] [CrossRef]
- Reddi, K.; Meghji, S.; Wilson, M.; Henderson, B. Comparison of the osteolytic activity of surface-associated proteins of bacteria implicated in periodontal disease. Oral Dis. 1995, 1, 26–31. [Google Scholar] [CrossRef]
- Choi, J.W.; Kim, S.C.; Hong, S.H.; Lee, H.J. Secretable Small RNAs via Outer Membrane Vesicles in Periodontal Pathogens. J. Dent. Res. 2017, 96, 458–466. [Google Scholar] [CrossRef]
- O’Donoghue, E.J.; Krachler, A.M. Mechanisms of outer membrane vesicle entry into host cells. Cell. Microbiol. 2016, 18, 1508–1517. [Google Scholar] [CrossRef]
- Kesty, N.C.; Mason, K.M.; Reedy, M.; Miller, S.E.; Kuehn, M.J. Enterotoxigenic Escherichia coli vesicles target toxin delivery into mammalian cells. EMBO J. 2004, 23, 4538–4549. [Google Scholar] [CrossRef]
- Nice, J.B.; Balashova, N.V.; Kachlany, S.C.; Koufos, E.; Krueger, E.; Lally, E.T.; Brown, A.C. Aggregatibacter actinomycetemcomitans Leukotoxin Is Delivered to Host Cells in an LFA-1-Indepdendent Manner When Associated with Outer Membrane Vesicles. Toxins 2018, 10, 414. [Google Scholar] [CrossRef] [PubMed]
- Ximenez-Fyvie, L.A.; Haffajee, A.D.; Socransky, S.S. Microbial composition of supra- and subgingival plaque in subjects with adult periodontitis. J. Clin. Periodontol. 2000, 27, 722–732. [Google Scholar] [CrossRef] [PubMed]
- Noiri, Y.; Li, L.; Ebisu, S. The localization of periodontal-disease-associated bacteria in human periodontal pockets. J. Dent. Res. 2001, 80, 1930–1934. [Google Scholar] [CrossRef] [PubMed]
- Christersson, L.A.; Albini, B.; Zambon, J.J.; Wikesjo, U.M.; Genco, R.J. Tissue localization of Actinobacillus actinomycetemcomitans in human periodontitis. I. Light, immunofluorescence and electron microscopic studies. J. Periodontol. 1987, 58, 529–539. [Google Scholar] [CrossRef] [PubMed]
- Colombo, A.V.; da Silva, C.M.; Haffajee, A.; Colombo, A.P. Identification of intracellular oral species within human crevicular epithelial cells from subjects with chronic periodontitis by fluorescence in situ hybridization. J. Periodontal Res. 2007, 42, 236–243. [Google Scholar] [CrossRef]
- Mendes, L.; Rocha, R.; Azevedo, A.S.; Ferreira, C.; Henriques, M.; Pinto, M.G.; Azevedo, N.F. Novel strategy to detect and locate periodontal pathogens: The PNA-FISH technique. Microbiol. Res. 2016, 192, 185–191. [Google Scholar] [CrossRef]
- Willi, M.; Belibasakis, G.N.; Bostanci, N. Expression and regulation of triggering receptor expressed on myeloid cells 1 in periodontal diseases. Clin. Exp. Immunol. 2014, 178, 190–200. [Google Scholar] [CrossRef]
- Thurnheer, T.; Belibasakis, G.N. Integration of non-oral bacteria into in vitro oral biofilms. Virulence 2015, 6, 258–264. [Google Scholar] [CrossRef]
- Bao, K.; Bostanci, N.; Selevsek, N.; Thurnheer, T.; Belibasakis, G.N. Quantitative proteomics reveal distinct protein regulations caused by Aggregatibacter actinomycetemcomitans within subgingival biofilms. PLoS ONE 2015, 10, e0119222. [Google Scholar] [CrossRef]
- Llama-Palacios, A.; Potupa, O.; Sanchez, M.C.; Figuero, E.; Herrera, D.; Sanz, M. Aggregatibacter actinomycetemcomitans Growth in Biofilm versus Planktonic State: Differential Expression of Proteins. J. Proteome Res. 2017, 16, 3158–3167. [Google Scholar] [CrossRef]
- Costerton, J.W.; Stewart, P.S.; Greenberg, E.P. Bacterial biofilms: A common cause of persistent infections. Science 1999, 284, 1318–1322. [Google Scholar] [CrossRef] [PubMed]
- Rathsam, C.; Eaton, R.E.; Simpson, C.L.; Browne, G.V.; Berg, T.; Harty, D.W.; Jacques, N.A. Up-regulation of competence- but not stress-responsive proteins accompanies an altered metabolic phenotype in Streptococcus mutans biofilms. Microbiology 2005, 151, 1823–1837. [Google Scholar] [CrossRef] [PubMed]
- Takasaki, K.; Fujise, O.; Miura, M.; Hamachi, T.; Maeda, K. Porphyromonas gingivalis displays a competitive advantage over Aggregatibacter actinomycetemcomitans in co-cultured biofilm. J. Periodontal Res. 2013, 48, 286–292. [Google Scholar] [CrossRef] [PubMed]
- Smith, K.P.; Voogt, R.D.; Ruiz, T.; Mintz, K.P. The conserved carboxyl domain of MorC, an inner membrane protein of Aggregatibacter actinomycetemcomitans, is essential for membrane function. Mol. Oral Microbiol. 2016, 31, 43–58. [Google Scholar] [CrossRef] [PubMed]
- Smith, K.P.; Fields, J.G.; Voogt, R.D.; Deng, B.; Lam, Y.W.; Mintz, K.P. Alteration in abundance of specific membrane proteins of Aggregatibacter actinomycetemcomitans is attributed to deletion of the inner membrane protein MorC. Proteomics 2015, 15, 1859–1867. [Google Scholar] [CrossRef]
- Zijnge, V.; Kieselbach, T.; Oscarsson, J. Proteomics of protein secretion by Aggregatibacter actinomycetemcomitans. PLoS ONE 2012, 7, e41662. [Google Scholar] [CrossRef]
- Rylev, M.; Abduljabar, A.B.; Reinholdt, J.; Ennibi, O.K.; Haubek, D.; Birkelund, S.; Kilian, M. Proteomic and immunoproteomic analysis of Aggregatibacter actinomycetemcomitans JP2 clone strain HK1651. J. Proteom. 2011, 74, 2972–2985. [Google Scholar] [CrossRef]
- Tendeng, C.; Bertin, P.N. H-NS in Gram-negative bacteria: A family of multifaceted proteins. Trends Microbiol. 2003, 11, 511–518. [Google Scholar] [CrossRef]
- Juarez, A.; Nieto, J.M.; Prenafeta, A.; Miquelay, E.; Balsalobre, C.; Carrascal, M.; Madrid, C. Interaction of the nucleoid-associated proteins Hha and H-NS to modulate expression of the hemolysin operon in Escherichia coli. Adv. Exp. Med. Biol. 2000, 485, 127–131. [Google Scholar] [CrossRef]
- Li, H.; Granat, A.; Stewart, V.; Gillespie, J.R. RpoS, H-NS, and DsrA influence EHEC hemolysin operon (ehxCABD) transcription in Escherichia coli O157:H7 strain EDL933. FEMS Microbiol. Lett. 2008, 285, 257–262. [Google Scholar] [CrossRef]
- Wang, H.; Ayala, J.C.; Benitez, J.A.; Silva, A.J. RNA-seq analysis identifies new genes regulated by the histone-like nucleoid structuring protein (H-NS) affecting Vibrio cholerae virulence, stress response and chemotaxis. PLoS ONE 2015, 10, e0118295. [Google Scholar] [CrossRef] [PubMed]
- Bao, K.; Belibasakis, G.N.; Selevsek, N.; Grossmann, J.; Bostanci, N. Proteomic profiling of host-biofilm interactions in an oral infection model resembling the periodontal pocket. Sci. Rep. 2015, 5, 15999. [Google Scholar] [CrossRef] [PubMed]
- Maughan, H.S.S.; Wilson, L.; Redfield, R. Competence, DNA Uptake and Transformation in Pasteurellaceae. In Pasteurellaceae Biology, Genomics and Molecular Aspects; Kuhnert, P., Christensen, H., Eds.; Caister Academic Press: Norfolk, UK, 2008; pp. 79–88. [Google Scholar]
- Fujise, O.; Lakio, L.; Wang, Y.; Asikainen, S.; Chen, C. Clonal distribution of natural competence in Actinobacillus actinomycetemcomitans. Oral Microbiol. Immunol. 2004, 19, 340–342. [Google Scholar] [CrossRef] [PubMed]
- Jorth, P.; Whiteley, M. An evolutionary link between natural transformation and CRISPR adaptive immunity. mBio 2012, 3. [Google Scholar] [CrossRef]
- Redfield, R.J.; Findlay, W.A.; Bosse, J.; Kroll, J.S.; Cameron, A.D.; Nash, J.H. Evolution of competence and DNA uptake specificity in the Pasteurellaceae. BMC Evol. Biol. 2006, 6, 82. [Google Scholar] [CrossRef]
- Wang, Y.; Shi, W.; Chen, W.; Chen, C. Type IV pilus gene homologs pilABCD are required for natural transformation in Actinobacillus actinomycetemcomitans. Gene 2003, 312, 249–255. [Google Scholar] [CrossRef]
- Tanaka, A.; Fujise, O.; Chen, C.; Miura, M.; Hamachi, T.; Maeda, K. A novel gene required for natural competence in Aggregatibacter actinomycetemcomitans. J. Periodontal Res. 2012, 47, 129–134. [Google Scholar] [CrossRef]
- Hisano, K.; Fujise, O.; Miura, M.; Hamachi, T.; Matsuzaki, E.; Nishimura, F. The pga gene cluster in Aggregatibacter actinomycetemcomitans is necessary for the development of natural competence in Ca2+-promoted biofilms. Mol. Oral Microbiol. 2014, 29, 79–89. [Google Scholar] [CrossRef]
- Wang, Y.; Goodman, S.D.; Redfield, R.J.; Chen, C. Natural transformation and DNA uptake signal sequences in Actinobacillus actinomycetemcomitans. J. Bacteriol. 2002, 184, 3442–3449. [Google Scholar] [CrossRef]
© 2019 by the authors. Licensee MDPI, Basel, Switzerland. This article is an open access article distributed under the terms and conditions of the Creative Commons Attribution (CC BY) license (http://creativecommons.org/licenses/by/4.0/).